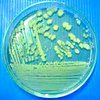

Richard Grosser
 Call It Stormy Monday (But Tuesday Is Just As Bad)
Call It Stormy Monday (But Tuesday Is Just As Bad) Love (on the) Rocks
Love (on the) Rocks Pop Corn
Pop Corn Idioteque (Redux)
Idioteque (Redux) The World Is A Ghetto
The World Is A Ghetto Can't Get Enough Of You Baby
Can't Get Enough Of You Baby Livin' Da Vida Loca
Livin' Da Vida Loca Bad Boys
Bad Boys Messenjah
Messenjah Red Red Wine
Red Red Wine Things Can Only Get Better
Things Can Only Get Better Redemption Song
Redemption Song Exodus
Exodus I Can See Clearly Now
I Can See Clearly Now Higher Ground
Higher Ground The Things We Do For Love
The Things We Do For Love Nothing Too Serious
Nothing Too Serious Dreadlock Holiday
Dreadlock Holiday Jet
Jet Revolutions
Revolutions Strange Ways
Strange Ways Friday I'm In Love
Friday I'm In Love Stumblin' In
Stumblin' In Ziggy Stardust
Ziggy Stardust Hot Love
Hot Love Perfect Day
Perfect Day Suspicious Minds
Suspicious Minds Twentieth Century Boy
Twentieth Century Boy Vanish Into You
Vanish Into You Ziggy Stardust
Ziggy Stardust Can The Can
Can The Can Nothing's Gonna Stop Us Now
Nothing's Gonna Stop Us Now Ballroom Blitz
Ballroom Blitz Jump
Jump Rebel Rebel
Rebel Rebel Tubular Bells
Tubular Bells Killer Queen
Killer Queen Golden Eye
Golden Eye Cum Feel The Noize
Cum Feel The Noize You Give Love A Bad Name
You Give Love A Bad Name Virginia Plain
Virginia Plain Only The Good Die Young
Only The Good Die Young All The Young Dudes
All The Young Dudes Mission Impossible
Mission Impossible Licence To Kill
Licence To Kill Jumpin' Jack Flash
Jumpin' Jack Flash I Believe In A Thing Called Love
I Believe In A Thing Called Love Electric Cafe
Electric Cafe Shout
Shout She Came In Through The Bathroom Window
She Came In Through The Bathroom Window Highway To Hell
Highway To Hell Too Many People
Too Many People The Man-Machine
The Man-Machine Blow Out
Blow Out Meglomania
Meglomania Behind Blue Eyes
Behind Blue Eyes Bell Bottom Blues
Bell Bottom Blues Over, Under, Sideways, Down
Over, Under, Sideways, Down Under My Thumb
Under My Thumb Endlessly
Endlessly Gallows Pole
Gallows Pole The Battle of Evermore
The Battle of Evermore For Your Eyes Only
For Your Eyes Only Back In Black
Back In Black Alter Ego
Alter Ego White Bird
White Bird In Your World
In Your World Hungarian Rhapsody No. 2 in C# Minor, S.244/2
Hungarian Rhapsody No. 2 in C# Minor, S.244/2 Get Up, Stand Up
Get Up, Stand Up Undisclosed Desires
Undisclosed Desires Voyager
Voyager Happy Trails
Happy Trails Without You
Without You Can't Take My Eyes Off Of You
Can't Take My Eyes Off Of You Black Dog
Black Dog Falling Down
Falling Down When The Levee Breaks
When The Levee Breaks Jesus bleibet meine Freude, BWV 147
Jesus bleibet meine Freude, BWV 147 Wild Is The Wind
Wild Is The Wind Lovely Rita
Lovely Rita Kid A
Kid A Hysteria (Redux)
Hysteria (Redux) America
America Endless Enigma [Part One]
Endless Enigma [Part One] Da Funk
Da Funk Cult
Cult Robot Rock
Robot Rock Unintended
Unintended Crippled Inside
Crippled Inside Mind Games
Mind Games Nights In White Satin
Nights In White Satin John Barleycorn (Must Die)
John Barleycorn (Must Die) All Time High
All Time High Do It Again
Do It Again Piano Man
Piano Man Dig Down
Dig Down When The Levee Breaks
When The Levee Breaks Everyday People
Everyday People Sky Pilot
Sky Pilot Setting Sun
Setting Sun The National Anthem (Again)
The National Anthem (Again) Thought Contagion
Thought Contagion Dedicated Follower Of Fashion
Dedicated Follower Of Fashion Baker Street
Baker Street Let My Love Open The Door
Let My Love Open The Door Force Majeure
Force Majeure I Still Call Australia Home
I Still Call Australia Home Shine On You Crazy Diamond
Shine On You Crazy Diamond The Kids Are Alright
The Kids Are Alright Big Boots
Big Boots Rain On Me
Rain On Me Daydreaming
Daydreaming Hey Joe
Hey Joe Moth Into Flame
Moth Into Flame Day After Day
Day After Day Baby Blue
Baby Blue Paparazzi
Paparazzi Liberation
Liberation In Your World
In Your World MK Ultra
MK Ultra Eyes Without A Face
Eyes Without A Face Sail To The Moon [with the Owl & the Pussycat]
Sail To The Moon [with the Owl & the Pussycat] Just Dance
Just Dance Born This Way
Born This Way Band On The Run
Band On The Run You Never Give Me Your Money
You Never Give Me Your Money Dolphin Dance
Dolphin Dance Stuntman
Stuntman Time
Time Girls Just Wanna Have Fun
Girls Just Wanna Have Fun Real Love
Real Love Baby Don't Cry
Baby Don't Cry Micro Cuts
Micro Cuts Aurora
Aurora Packt Like Sardines In a Crushd Tin Box
Packt Like Sardines In a Crushd Tin Box Problem
Problem Dead Inside
Dead Inside Mars The Bringer Of War
Mars The Bringer Of War Light My Fire
Light My Fire Flash (Rewound)
Flash (Rewound) Genesis Ch.1 Vs. 32
Genesis Ch.1 Vs. 32 Renegades Of Funk
Renegades Of Funk Guerrilla Radio
Guerrilla Radio Citizen Erased
Citizen Erased Eternal Flame
Eternal Flame The King Of Denmark's Galliard (LOST reMASTER)
The King Of Denmark's Galliard (LOST reMASTER) We Are Never Ever Getting Back Together (LOST reMASTER)
We Are Never Ever Getting Back Together (LOST reMASTER) Plug In Baby! (LOST reMASTER)
Plug In Baby! (LOST reMASTER) Beat It! (LOST reMaster)
Beat It! (LOST reMaster) Hash Pipe
Hash Pipe Muscle Museum
Muscle Museum Paradise
Paradise Harder Better Faster Stronger
Harder Better Faster Stronger Love Will Tear Us Apart
Love Will Tear Us Apart Kaleid
Kaleid Blackstar
Blackstar Knife-Edge
Knife-Edge How Deep Is Your Love
How Deep Is Your Love Enter Sandman (Again)
Enter Sandman (Again) Islands In The Stream
Islands In The Stream Monkberry Moon Delight (Redux)
Monkberry Moon Delight (Redux) All Along The Watchtower
All Along The Watchtower Teardrop
Teardrop Summertime Blues
Summertime Blues Feel Good Inc.
Feel Good Inc. Alter Ego
Alter Ego Won't Get Fooled Again
Won't Get Fooled Again Devil In Disguise
Devil In Disguise High & Dry (Broken Bank Edition)
High & Dry (Broken Bank Edition) Itchycoo Park
Itchycoo Park An Innocent Man
An Innocent Man Born Slippy [Untimely Ripped]
Born Slippy [Untimely Ripped] My Sharona
My Sharona Starlight
Starlight Pictures Of Lily
Pictures Of Lily Baba O'Riley
Baba O'Riley Savoy Truffle
Savoy Truffle Pumped Up Kicks
Pumped Up Kicks The Middle
The Middle Uprising
Uprising Long Tall Sally
Long Tall Sally Yes It Is
Yes It Is Like A Rolling Stone (Redux)
Like A Rolling Stone (Redux) She Sells Sanctuary
She Sells Sanctuary Mad World
Mad World Regret
Regret The Kids Are Alright
The Kids Are Alright Born To Be Wild
Born To Be Wild Running Bear
Running Bear Eye Of The Tiger
Eye Of The Tiger Teddy Bear
Teddy Bear Baby Elephant Walk
Baby Elephant Walk The Lion Sleeps Tonight
The Lion Sleeps Tonight Us And Them (Redux)
Us And Them (Redux) Missing You
Missing You Kiss Me
Kiss Me Bach: Partita in D Minor, BWV 1004: 5. Chaconne.
Bach: Partita in D Minor, BWV 1004: 5. Chaconne. Fearless
Fearless When Doves Cry
When Doves Cry Eminence Front
Eminence Front Roundabout
Roundabout Schubert: Rondo brilliant in B Minor, Op. 70, D. 895
Schubert: Rondo brilliant in B Minor, Op. 70, D. 895 C'est La Vie
C'est La Vie Saturnz Barz (Spirit House)
Saturnz Barz (Spirit House) Tender
Tender What Do You Want From Me (Redux)
What Do You Want From Me (Redux) Smells Like Teen Spirit
Smells Like Teen Spirit Main Title/Trinity Infinity [From 'The Matrix']
Main Title/Trinity Infinity [From 'The Matrix'] Atom Heart Mother
Atom Heart Mother Funkytown
Funkytown Grosse Fuge
Grosse Fuge Inbetween Days
Inbetween Days Venus
Venus Shout
Shout The Numbers (2024 Edition)
The Numbers (2024 Edition) Bad To Me
Bad To Me Inside My Head (Redux)
Inside My Head (Redux) Europa
Europa Oye Como Va
Oye Como Va Samba Pa Ti
Samba Pa Ti Thriller
Thriller Walk Right Back (Redux)
Walk Right Back (Redux) Everybody's Everything
Everybody's Everything Siberian Khatru
Siberian Khatru Close To The Edge
Close To The Edge Dirty Love
Dirty Love Heart Of The Sunrise
Heart Of The Sunrise I've Seen All Good People
I've Seen All Good People Forever Young
Forever Young Good Riddance
Good Riddance We Have All The Time In The World
We Have All The Time In The World Mozart: Requiem, in Dm, K.626: No. 12
Mozart: Requiem, in Dm, K.626: No. 12 That Don't Impress Me Much
That Don't Impress Me Much Peaches en Regalia
Peaches en Regalia Sunburn
Sunburn Only Women Bleed
Only Women Bleed Jump In The Line
Jump In The Line Mozart: Requiem in Dm, K. 626: No. 12
Mozart: Requiem in Dm, K. 626: No. 12 Echoes
Echoes Stockholm Syndrome
Stockholm Syndrome Breathe
Breathe Ace Of Spades
Ace Of Spades I Won't Back Down
I Won't Back Down The Wind Cries Mary
The Wind Cries Mary Personal Jesus (Redux)
Personal Jesus (Redux) Stone Free
Stone Free Hurt
Hurt Fly Me To The Moon
Fly Me To The Moon Golden Brown
Golden Brown Ghostbusters
Ghostbusters The Last Starfighter
The Last Starfighter Paparazzi
Paparazzi What Time Is Love?
What Time Is Love? All That She Wants
All That She Wants Hysteria
Hysteria Don't Worry Baby
Don't Worry Baby Hotel California
Hotel California Beethoven: Piano Sonata No. 14
Beethoven: Piano Sonata No. 14 Wonderwall
Wonderwall Rip It Up
Rip It Up Torn (again)
Torn (again) Never Tear Us Apart (Redux)
Never Tear Us Apart (Redux) Pearly
Pearly House Of Cards
House Of Cards Mozart: Serenade [No. 13] in G Major for string orchestra, K 525 (Eine kleine Nachtmusik) - Movement No. 2, Andante.
Mozart: Serenade [No. 13] in G Major for string orchestra, K 525 (Eine kleine Nachtmusik) - Movement No. 2, Andante. Mozart: Serenade [No. 13] in G Major for string orchestra, K 525 (Eine kleine Nachtmusik) - Movement No. 1, Allegro.
Mozart: Serenade [No. 13] in G Major for string orchestra, K 525 (Eine kleine Nachtmusik) - Movement No. 1, Allegro. Push It
Push It Bodysnatchers
Bodysnatchers Inca Roads
Inca Roads Smoke On The Water
Smoke On The Water Paranoid
Paranoid (Thinking about) Last Night
(Thinking about) Last Night Never Gonna Give You Up
Never Gonna Give You Up (Red Hot) Higher Ground
(Red Hot) Higher Ground Take It Easy
Take It Easy Concerto For Two Violins in Dm BMV 1043
Concerto For Two Violins in Dm BMV 1043 On The Turning Away
On The Turning Away Beautiful Boy
Beautiful Boy Beethoven: Piano Sonata No. 30, Op. 109
Beethoven: Piano Sonata No. 30, Op. 109 True
True What's Love Got To Do With It
What's Love Got To Do With It World In My Eyes
World In My Eyes Higher Ground
Higher Ground Fly
Fly Everything's Alright
Everything's Alright Jerusalem (Unbound)
Jerusalem (Unbound) Superstition
Superstition You Can Get It If You Really Want
You Can Get It If You Really Want Doggie In The Window
Doggie In The Window Epitaph
Epitaph Walk Like An Egyptian
Walk Like An Egyptian Push The Button
Push The Button Banana Co. (Redux)
Banana Co. (Redux) Glass Eyes
Glass Eyes Bishop's Robes
Bishop's Robes Decks Dark
Decks Dark Beethoven: Symphony No. 3 in Eb Major (Eroica). IV. Finale. Allegro molto – Poco
Beethoven: Symphony No. 3 in Eb Major (Eroica). IV. Finale. Allegro molto – Poco Beethoven: Symphony No. 3 in Eb Major (Eroica) - II. Marcia funebre. Adagio assai
Beethoven: Symphony No. 3 in Eb Major (Eroica) - II. Marcia funebre. Adagio assai Beethoven: Symphony No. 3 in Eb Major (Eroica). III. Scherzo. Allegro vivace – Trio
Beethoven: Symphony No. 3 in Eb Major (Eroica). III. Scherzo. Allegro vivace – Trio Beethoven: Symphony No. 3 in Eb Major (Eroica) - I. Allegro con brio
Beethoven: Symphony No. 3 in Eb Major (Eroica) - I. Allegro con brio The Robots
The Robots Set The Controls (For The Heart Of The Sun)
Set The Controls (For The Heart Of The Sun) Anyone Can Play Guitar
Anyone Can Play Guitar Gold
Gold The Yellow Rose (Of Texas)
The Yellow Rose (Of Texas) Yellow
Yellow Jennifer Juniper
Jennifer Juniper The Season Of The Witch
The Season Of The Witch Copland: Fanfare For The Common Man
Copland: Fanfare For The Common Man Feeling Good
Feeling Good True Love Waits [next in line]
True Love Waits [next in line] Fake Plastic Trees [pre-fab assemblage]
Fake Plastic Trees [pre-fab assemblage] Mussorgsky: Pictures At An Exhibition - The Gnome
Mussorgsky: Pictures At An Exhibition - The Gnome Lucky Man
Lucky Man I Am Citizen Insane
I Am Citizen Insane Like A Rolling Stone
Like A Rolling Stone Paperbag Writer
Paperbag Writer Subterranean Homesick Blues
Subterranean Homesick Blues Sweet Home Alabama
Sweet Home Alabama Call Me The Breeze
Call Me The Breeze Mellow Yellow
Mellow Yellow Sunshine Superman
Sunshine Superman The Fool On The Hill
The Fool On The Hill I'm Down
I'm Down How Soon Is Now?
How Soon Is Now? Hand In Glove
Hand In Glove This Charming Man
This Charming Man The Terminator
The Terminator A Night Like This
A Night Like This Lovesong
Lovesong I'll Cry Instead
I'll Cry Instead J.S. Bach: Sonata for Solo Guitar No. 1 in G Minor, BWM 1001
J.S. Bach: Sonata for Solo Guitar No. 1 in G Minor, BWM 1001 A Hard Day's Night
A Hard Day's Night Sultans Of Swing
Sultans Of Swing JMJ Medley
JMJ Medley Sit Down, Stand Up
Sit Down, Stand Up Peter Gunn
Peter Gunn Let It Happen
Let It Happen From The Beginning
From The Beginning All Out Of Love
All Out Of Love The Naked Gun
The Naked Gun Shaft
Shaft Axel F
Axel F Don't You (Forget About Me)
Don't You (Forget About Me) Antarctica
Antarctica Holiday
Holiday Elephant-ine
Elephant-ine Flying
Flying Galaxy Quest
Galaxy Quest Bad Guy
Bad Guy As Long As I Can See The Light
As Long As I Can See The Light Pretty Fly (For A White Guy)
Pretty Fly (For A White Guy) Seven Wonders
Seven Wonders All Time High
All Time High Take On Me
Take On Me Photograph
Photograph Codex
Codex Happy Christmas [War Is Over]
Happy Christmas [War Is Over] Bloom
Bloom Christmas Carols
Christmas Carols Mozart: Clarinet Quintet
Mozart: Clarinet Quintet In My Life
In My Life Can't Find My Way Home
Can't Find My Way Home Dear Mr Fantasy
Dear Mr Fantasy Brazil
Brazil Lightning Crashes
Lightning Crashes Wonderful Land
Wonderful Land I Can See For Miles
I Can See For Miles Abracadabra
Abracadabra I'm A Man
I'm A Man Lucky Lips
Lucky Lips (Baby I've Got You) On My Mind
(Baby I've Got You) On My Mind Passenger
Passenger Please Please Me
Please Please Me S.O.S.
S.O.S. Barbara Ann
Barbara Ann Misty Mountain Hop
Misty Mountain Hop Hey Jude
Hey Jude Loops Of Fury 2
Loops Of Fury 2 Let Forever Be
Let Forever Be Wouldn't It Be Nice
Wouldn't It Be Nice Good Vibrations
Good Vibrations California Dreamin'
California Dreamin' Menuetto KV 581
Menuetto KV 581 Polyethylene [Parts 1 & 2] (Redux)
Polyethylene [Parts 1 & 2] (Redux) Desert Island Disk
Desert Island Disk The Skye Boat Song
The Skye Boat Song Blow Away
Blow Away The Mighty Quinn
The Mighty Quinn Knives Out (Mouser Remix)
Knives Out (Mouser Remix) Every Night
Every Night Faith
Faith Ventura Highway
Ventura Highway Take A Look At Me Now
Take A Look At Me Now Licence To Kill
Licence To Kill Baby You're The Best
Baby You're The Best Tomorrow Never Dies [4K Version]
Tomorrow Never Dies [4K Version] Life Of My Own
Life Of My Own View To A Kill
View To A Kill Best Of My Love
Best Of My Love Aurora
Aurora Changing Of The Guard
Changing Of The Guard Gaza Jazz
Gaza Jazz God Is A DJ (Vox Vesperarum)
God Is A DJ (Vox Vesperarum) Day After Day
Day After Day Do Ya
Do Ya Bad Boys
Bad Boys From Russia With Love
From Russia With Love Live And Let Die (Panicked Version)
Live And Let Die (Panicked Version) Had To Cry Today
Had To Cry Today Blue Christmas
Blue Christmas Dreams
Dreams In Limbo
In Limbo Electioneering
Electioneering Sleep Together
Sleep Together House Of Cards
House Of Cards The World Is Not Enough
The World Is Not Enough Nanjing Fall
Nanjing Fall Karma Police
Karma Police I Shot The Sheriff
I Shot The Sheriff Get Up, Stand Up
Get Up, Stand Up Suspicious Minds
Suspicious Minds Good Enough
Good Enough Baby One More Time
Baby One More Time True Love
True Love Walking Back to Happiness
Walking Back to Happiness Walk Right Back
Walk Right Back Blackbird
Blackbird Shake It Off
Shake It Off Computer Love
Computer Love Clint Eastwood
Clint Eastwood I'm So Excited
I'm So Excited Needles And Pins
Needles And Pins There There (Extended Edition)
There There (Extended Edition) Handle With Care
Handle With Care Last Night
Last Night My Happiness
My Happiness Mean
Mean The Court Of The Crimson King (Redux)
The Court Of The Crimson King (Redux) Frame By Frame
Frame By Frame Shut Your Mouth
Shut Your Mouth With A Little Help From My Friends
With A Little Help From My Friends Fly Like An Eagle
Fly Like An Eagle Little By Little
Little By Little You Belong With Me
You Belong With Me Tree Fingers
Tree Fingers You've Got Another Thing Comin'
You've Got Another Thing Comin' Thunderball
Thunderball Inside My Head
Inside My Head Where Is My Mind?
Where Is My Mind? Lay Lady Lay
Lay Lady Lay The Last Train To Clarksville
The Last Train To Clarksville She's A Woman
She's A Woman Like A Rolling Stone
Like A Rolling Stone La Bamba
La Bamba HALO Theme
HALO Theme Lady Of The Dancing Water
Lady Of The Dancing Water Cirkus
Cirkus Epitaph
Epitaph Over The Rainbow
Over The Rainbow Black
Black Goldfinger
Goldfinger JAG Theme
JAG Theme Also Spracht Zarathustra
Also Spracht Zarathustra Chains
Chains Bobby Brown
Bobby Brown Out Of Time
Out Of Time White Room
White Room Rachmaninov: Prelude No. 1 in C-Sharp Minor, Op. 3 No. 2
Rachmaninov: Prelude No. 1 in C-Sharp Minor, Op. 3 No. 2 Will Of The People
Will Of The People We Are Never Ever Getting Back Together
We Are Never Ever Getting Back Together Love Is In The Air
Love Is In The Air Crossroads 1968
Crossroads 1968 Crossroads 1936
Crossroads 1936 Black
Black Auf Weidersehen
Auf Weidersehen The Imperial March
The Imperial March Red Red Wine
Red Red Wine Still Got The Blues [For You]
Still Got The Blues [For You] Born Slippy [Hurler Version]
Born Slippy [Hurler Version] Liberation
Liberation Love Story
Love Story My Country
My Country Dueling Banjos
Dueling Banjos Blue Skies
Blue Skies Nothing Else Matters
Nothing Else Matters (Been) Thinking About You
(Been) Thinking About You Waldstein (No. 2)
Waldstein (No. 2) Ain't That A Shame
Ain't That A Shame 21st Century Schizoid Man
21st Century Schizoid Man Crying Shame
Crying Shame Soul Sacrifice
Soul Sacrifice Never Goin' Back Again
Never Goin' Back Again Come On My My Kitchen
Come On My My Kitchen Boys
Boys Surrender
Surrender Empty Garden
Empty Garden Turn! Turn! Turn!
Turn! Turn! Turn! Faust Arp (Dante's Waltz Version)
Faust Arp (Dante's Waltz Version) Let Down
Let Down No Surprises
No Surprises Prove Yourself
Prove Yourself James Bond Theme
James Bond Theme Dream Police
Dream Police The Scientist
The Scientist Myxomatosis (Burning Black Hole Version)
Myxomatosis (Burning Black Hole Version) The Concerto for Two Violins in Dm, BWV 1043: 3
The Concerto for Two Violins in Dm, BWV 1043: 3 The Concerto for Two Violins in Dm, BWV 1043: 2
The Concerto for Two Violins in Dm, BWV 1043: 2 The Concerto for Two Violins in Dm, BWV 1043: 1
The Concerto for Two Violins in Dm, BWV 1043: 1 Knockin' On Heaven's Door
Knockin' On Heaven's Door Bad Moon Rising
Bad Moon Rising Viva La Vida
Viva La Vida Bodysnatchers (Pod Edition)
Bodysnatchers (Pod Edition) What Do You Want From Me
What Do You Want From Me Get It On (Bang A Gong)
Get It On (Bang A Gong) I'm Not In Love
I'm Not In Love Waldstein
Waldstein Stockholm Syndrome
Stockholm Syndrome Teenage Dirtbag
Teenage Dirtbag The Low Spark Of High-Heeled Boys
The Low Spark Of High-Heeled Boys Gimme Some Lovin'
Gimme Some Lovin' Trio No.7, Op. 97: 3 & 4
Trio No.7, Op. 97: 3 & 4 Trio No.7, Op. 97: 2
Trio No.7, Op. 97: 2 Trio No.7, Op. 97: 1
Trio No.7, Op. 97: 1 Handle With Care
Handle With Care Congratulations
Congratulations Everything In It's Right Place (Two Colour Edition)
Everything In It's Right Place (Two Colour Edition) Maquiladora
Maquiladora Where Is The Love
Where Is The Love Talk Show Host [Narrowcast Version]
Talk Show Host [Narrowcast Version] Oxygene 8
Oxygene 8 Mr. Moonlight
Mr. Moonlight Plugin Baby
Plugin Baby NeverEnding Story
NeverEnding Story Euphoria (Synsational RMX)
Euphoria (Synsational RMX) Black Night
Black Night One Love (Feel Alright RMX)
One Love (Feel Alright RMX) Summer In The City
Summer In The City Oxygene, Pt. 6
Oxygene, Pt. 6 The Model (Strange Attractor)
The Model (Strange Attractor) For Your Love
For Your Love Eye Of the Tiger
Eye Of the Tiger The King Of Denmark's Galliard
The King Of Denmark's Galliard Dollars And Cents (Plastic Edition)
Dollars And Cents (Plastic Edition) The Mother We All Share
The Mother We All Share For No One (Zed RMX)
For No One (Zed RMX) Somebody's Watching Me
Somebody's Watching Me Somebody Dance With Me
Somebody Dance With Me Electric Cafe (Burts Milk Bar RMX)
Electric Cafe (Burts Milk Bar RMX) Hold The Line
Hold The Line Killing In The Name
Killing In The Name One Love (Cold Moon Edition)
One Love (Cold Moon Edition) Waiting In Vain
Waiting In Vain Fairytale of New York
Fairytale of New York Chariots Of Fire
Chariots Of Fire All Those Years Ago
All Those Years Ago Where The Streets Have No Name
Where The Streets Have No Name The End
The End Don't Fear The Reaper (Vestibular RMX)
Don't Fear The Reaper (Vestibular RMX) Africa (Hwange RMX)
Africa (Hwange RMX) My Generation
My Generation Beat It
Beat It Prayers For Rain
Prayers For Rain Under The Sea
Under The Sea There Is A Light That Never Goes Out
There Is A Light That Never Goes Out How Soon Is Now?
How Soon Is Now? This Masquerade
This Masquerade Bangladesh
Bangladesh A Day In The Life
A Day In The Life True Love Waits (Redux)
True Love Waits (Redux) 2+2=5 (The Lukewarm)
2+2=5 (The Lukewarm) Give Me Love
Give Me Love I Will
I Will Long Tall Sally
Long Tall Sally Prelude and Fugue in Em
Prelude and Fugue in Em Imagine
Imagine Rumble (In The Jungle)
Rumble (In The Jungle) High And Dry (Beached RMX)
High And Dry (Beached RMX) Just Like Heaven (Feather Cut Version)
Just Like Heaven (Feather Cut Version) Monkberry Moon Delight
Monkberry Moon Delight Photograph
Photograph Thinking About You
Thinking About You Cars
Cars Karelia Suite, Op. 11: 1. Intermezzo (Moderato)
Karelia Suite, Op. 11: 1. Intermezzo (Moderato) Symphony No. 40 in G Minor, K. 550: I. Molto allegro
Symphony No. 40 in G Minor, K. 550: I. Molto allegro Yes I Am
Yes I Am Piano Sonata No.8, Op.13 'Pathetique'
Piano Sonata No.8, Op.13 'Pathetique' Alligators In New York Sewers
Alligators In New York Sewers Land Of Confusion
Land Of Confusion Fugue
Fugue I Might Be Wrong (Redoubled)
I Might Be Wrong (Redoubled) Connected
Connected Stop Whispering (Jack's Lament)
Stop Whispering (Jack's Lament) All Things Must Pass
All Things Must Pass Ständchen (Serenade) D957-4
Ständchen (Serenade) D957-4 Eyes Wide Open
Eyes Wide Open Larks' Tongues in Aspic (Part II)
Larks' Tongues in Aspic (Part II) Starless
Starless Break On Through (To the Other Side)
Break On Through (To the Other Side) Do-Wah-Diddy
Do-Wah-Diddy Everything In It's Right Place (Free RMX)
Everything In It's Right Place (Free RMX) Ramblin' Man
Ramblin' Man Sit Down Stand Up
Sit Down Stand Up Bullet Proof ... I Wish I Was
Bullet Proof ... I Wish I Was What Becomes Of The Brokenhearted
What Becomes Of The Brokenhearted The Tourist
The Tourist Gypsy (Deluxe RMX)
Gypsy (Deluxe RMX) Squinch
Squinch Beautiful Day
Beautiful Day Tears In Heaven
Tears In Heaven Everybody's Got To Learn Sometime
Everybody's Got To Learn Sometime Ceremony
Ceremony Something Just Like This
Something Just Like This You Only Live Twice (Redux)
You Only Live Twice (Redux) Golden Eye
Golden Eye Jump
Jump Evil Woman
Evil Woman Just Like Starting Over
Just Like Starting Over Mr. K.
Mr. K. Free Fallin'
Free Fallin' All Right Now
All Right Now Moonshadow
Moonshadow Paranoid
Paranoid Give Peace A Chance
Give Peace A Chance Children Of The Sea
Children Of The Sea 25 or 6 to 4
25 or 6 to 4 If You Leave Me Now
If You Leave Me Now Anthem For The Year 2000
Anthem For The Year 2000 Another Brick In The Wall (Part II)
Another Brick In The Wall (Part II) The Air That I Breathe
The Air That I Breathe Hard As A Rock
Hard As A Rock It's Gonna Get Better
It's Gonna Get Better I Can't Dance
I Can't Dance Locomotion
Locomotion Fade Out (Again)
Fade Out (Again) Weird Fishes/ Arpeggi
Weird Fishes/ Arpeggi Underneath The Radar
Underneath The Radar Californication
Californication Lady Jane
Lady Jane Blue Suede Shoes
Blue Suede Shoes Tonight Tonight
Tonight Tonight 4 Minute Warning (Redux)
4 Minute Warning (Redux) Bones
Bones Black Hole Sun
Black Hole Sun That's The Way (I Like It)
That's The Way (I Like It) I Want You To Want Me
I Want You To Want Me Radio-Activity
Radio-Activity Musik ohne Ende
Musik ohne Ende Where I End And You Begin [Redux]
Where I End And You Begin [Redux] Lookin' Out My Back Door
Lookin' Out My Back Door Walkin' The Dog
Walkin' The Dog Under My Thumb
Under My Thumb U Got The Look
U Got The Look Purple Rain (Appalachian Plateau Version)
Purple Rain (Appalachian Plateau Version) Raspberry Beret
Raspberry Beret 1999 (Redux)
1999 (Redux) Ode To Joy
Ode To Joy Die Zauberflöte: Die Königin der Nacht
Die Zauberflöte: Die Königin der Nacht Magical Mystery Tour
Magical Mystery Tour Magic Bus
Magic Bus Burnin' For You
Burnin' For You Domino
Domino You're My Best Friend
You're My Best Friend Heart Of Glass
Heart Of Glass I Believe In Father Christmas
I Believe In Father Christmas Maneater
Maneater Creep (Slinky RMX)
Creep (Slinky RMX) Driver's Seat
Driver's Seat Whip It
Whip It Under The Milky Way
Under The Milky Way Street Hassle (Waltzing Matilda)
Street Hassle (Waltzing Matilda) Electric Blue
Electric Blue Dead End Street
Dead End Street Barabajagal
Barabajagal Airwaves
Airwaves Heartbreaker
Heartbreaker Climbing Up The Walls
Climbing Up The Walls When I Paint My Masterpiece
When I Paint My Masterpiece Shout
Shout Macarena
Macarena I'm Only Sleeping
I'm Only Sleeping Tomorrow Belongs To Me
Tomorrow Belongs To Me Airbag (Crash-Test Version)
Airbag (Crash-Test Version) My Guitar Gently Weeps
My Guitar Gently Weeps Freight Train
Freight Train 777-9311
777-9311 Nothing Compares 2 U
Nothing Compares 2 U Magic
Magic Sail To The Moon
Sail To The Moon Sweet Child O' Mine
Sweet Child O' Mine Two Strong Hearts
Two Strong Hearts All Right Now
All Right Now Country Roads
Country Roads Do Me, Baby
Do Me, Baby Rabbit (In Your Headlights)
Rabbit (In Your Headlights) No Time To Die
No Time To Die Ripcord (Redux)
Ripcord (Redux) Part-Time Lover
Part-Time Lover A Horse With No Name
A Horse With No Name When Will I Be Loved
When Will I Be Loved True Love Waits
True Love Waits Force Majeure
Force Majeure When Will I See You Again
When Will I See You Again Venus And Mars
Venus And Mars Third Stone From The Sun
Third Stone From The Sun Lady Blue
Lady Blue Only The Lonely
Only The Lonely Still... You Turn Me On
Still... You Turn Me On One Of These Days
One Of These Days Venus
Venus Teddy Boy
Teddy Boy Do You Want To Know A Secret
Do You Want To Know A Secret Rocket Man (Glastonbury Version)
Rocket Man (Glastonbury Version) Oh My Love
Oh My Love Junk
Junk Let Me Roll It
Let Me Roll It Be True To Your School
Be True To Your School Purple Rain [Madcat Edition]
Purple Rain [Madcat Edition] Philby
Philby School
School Big Love (360º Version)
Big Love (360º Version) Lurgee
Lurgee The Court Of the Crimson King
The Court Of the Crimson King Violin Concerto No. 2 in E Major, BWV 1042: 1. Allegro
Violin Concerto No. 2 in E Major, BWV 1042: 1. Allegro More Than A Feeling
More Than A Feeling Child In Time
Child In Time Rudy
Rudy Gypsy
Gypsy Moby Dick (Queequeg's Lament)
Moby Dick (Queequeg's Lament) Call Of Ktulu
Call Of Ktulu How Do You?
How Do You? Tales Of Brave Ulysses (Sirens Chorus)
Tales Of Brave Ulysses (Sirens Chorus) Outside Woman Blues
Outside Woman Blues True
True Golden Brown
Golden Brown Highway Star
Highway Star Sister Moonshine
Sister Moonshine Chicago
Chicago Gold
Gold Dirty Work
Dirty Work Ordinary World
Ordinary World Hold Me
Hold Me Just (Conflict Resolution Version)
Just (Conflict Resolution Version) Machine Gun
Machine Gun American Pie
American Pie Little Red Corvette
Little Red Corvette Meeting In The Aisle
Meeting In The Aisle Mystery To Me
Mystery To Me Autobahn (EV Version)
Autobahn (EV Version) The Model (The DIVA's Return)
The Model (The DIVA's Return) A Saucerful Of Secrets
A Saucerful Of Secrets Round And Around
Round And Around Comfortably Numb (Methos RMX)
Comfortably Numb (Methos RMX) Highway To Hell
Highway To Hell Hypnotized
Hypnotized Oh Well
Oh Well You
You A Place In The Sun
A Place In The Sun Myxomatosis
Myxomatosis One Love
One Love Robotronik
Robotronik Paperback Writer
Paperback Writer I've Seen All Good People
I've Seen All Good People Pocket Calculator (NOVA Version)
Pocket Calculator (NOVA Version) Neon Lights (PTEq-X Version)
Neon Lights (PTEq-X Version) Pictures Of You (CODE RED Version)
Pictures Of You (CODE RED Version) Neon Lights
Neon Lights Wild Horses
Wild Horses Pictures Of You
Pictures Of You Pocket Calculator
Pocket Calculator Franz Schubert
Franz Schubert Tarkus (Trinity RMX)
Tarkus (Trinity RMX) Videotape (Rewound)
Videotape (Rewound) Radioactivity
Radioactivity From The Beginning
From The Beginning Tour de France
Tour de France Vegetable
Vegetable Benny
Benny The Robots
The Robots Hoedown
Hoedown Man-Machine
Man-Machine Interstellar Overdrive (Mess-Hall RMX)
Interstellar Overdrive (Mess-Hall RMX) Run Like Hell (IPCC Version)
Run Like Hell (IPCC Version) Uptown Girl
Uptown Girl Interstellar OD
Interstellar OD Oxygene, Pt. 4
Oxygene, Pt. 4 Oxygene, Pt. 6
Oxygene, Pt. 6 Prove Yourself
Prove Yourself Hungry Like The Wolf
Hungry Like The Wolf I Can't
I Can't London Calling
London Calling Graceland
Graceland West End Girls
West End Girls Us And Them
Us And Them Enola Gay
Enola Gay ChatGPT: Gilmour Riff
ChatGPT: Gilmour Riff Computerwelt
Computerwelt Electric Cafe
Electric Cafe Nothing As It Seems (Redux)
Nothing As It Seems (Redux) Beds Are Burning
Beds Are Burning Africa Unite
Africa Unite It's Raining Again
It's Raining Again Sunshine Day (Redux)
Sunshine Day (Redux) Castles Made Of Sand
Castles Made Of Sand Special
Special We Suck Young Blood
We Suck Young Blood Private Eyes
Private Eyes Caribbean Queen
Caribbean Queen Epic
Epic Beautiful Child
Beautiful Child Exodus
Exodus Tomorrow
Tomorrow If I Needed Someone
If I Needed Someone Bring It On Home To Me
Bring It On Home To Me Steal My Kisses
Steal My Kisses God Only Knows (Multi-Part RMX)
God Only Knows (Multi-Part RMX) White Flag
White Flag Never Let Me Down Again
Never Let Me Down Again Pretzel Logic
Pretzel Logic Listen To The Music
Listen To The Music Knives Out
Knives Out Man! I Feel Like A Woman!
Man! I Feel Like A Woman! Bell Bottom Blues
Bell Bottom Blues Go Slowly
Go Slowly Blow Out
Blow Out Take The Power Back
Take The Power Back Bullet In The Head
Bullet In The Head Live And Let Die
Live And Let Die Licence To Kill
Licence To Kill Banana Co
Banana Co Smoke On the Water
Smoke On the Water The Unforgiven (Supplication RMX)
The Unforgiven (Supplication RMX) Are You Lonesome Tonight?
Are You Lonesome Tonight? War Pigs
War Pigs Marrakesh Express
Marrakesh Express Brown Sugar
Brown Sugar Nowhere Man
Nowhere Man Teach Your Children
Teach Your Children Gimme Shelter (Bushmaster RMX)
Gimme Shelter (Bushmaster RMX) Violin Concerto in D Major, Op. 61: 1
Violin Concerto in D Major, Op. 61: 1 Wait Until Tomorrow (Uneasy RMX)
Wait Until Tomorrow (Uneasy RMX) Do It Again
Do It Again Our House
Our House Suite: Judy Blue Eyes (Extended Mix)
Suite: Judy Blue Eyes (Extended Mix) Lozenge Of Love
Lozenge Of Love Southern Cross
Southern Cross Speed Of Sound
Speed Of Sound Bodhisattva (Extended Mix)
Bodhisattva (Extended Mix) Paradise
Paradise Heart Of Stone
Heart Of Stone Ceremony
Ceremony Separator
Separator Mr Tambourine Man
Mr Tambourine Man Sonata 13, in BbM, KV 333
Sonata 13, in BbM, KV 333 Do Wah Diddy Diddy
Do Wah Diddy Diddy Whip It!
Whip It! Eye Of The Tiger
Eye Of The Tiger The King of Denmark's Galliard
The King of Denmark's Galliard I've Just Seen A Face
I've Just Seen A Face Blue Monday (Joyful RMX)
Blue Monday (Joyful RMX) Blue Monday (Emu RMX)
Blue Monday (Emu RMX) If We Ever Meet Again
If We Ever Meet Again Blue Monday
Blue Monday Greensleeves (Jeff Beck Version)
Greensleeves (Jeff Beck Version) Regret
Regret The Rockets Red Glare
The Rockets Red Glare Evil Ways
Evil Ways Moonlight Sonata, Op. 27, No. 2 (First Movement)
Moonlight Sonata, Op. 27, No. 2 (First Movement) Jesu Joy Of Man's Desiring (Guitar + Kalimba)
Jesu Joy Of Man's Desiring (Guitar + Kalimba) The Last Time (Kalimba Synth)
The Last Time (Kalimba Synth) The Last Time
The Last Time Glass Onion
Glass Onion Big Ideas
Big Ideas Dream Weaver
Dream Weaver It's All Over Now
It's All Over Now The Present Tense (Past Participle)
The Present Tense (Past Participle) (You Gotta) Fight For Your Right (To Party!)
(You Gotta) Fight For Your Right (To Party!) Rip This Joint (Tally-Ho RMX)
Rip This Joint (Tally-Ho RMX) The Chain
The Chain Your Cheatin' Heart
Your Cheatin' Heart Dancing With The Moonlit Knight
Dancing With The Moonlit Knight Pictures At An Exhibition
Pictures At An Exhibition God Is A DJ (Bliss RMX)
God Is A DJ (Bliss RMX) The Hippy Hippy Shake
The Hippy Hippy Shake The Trickster
The Trickster Thunderstruck (Santus Remisceo)
Thunderstruck (Santus Remisceo) Drive
Drive Knockin' On Heaven's Door (Weeping Angel Version)
Knockin' On Heaven's Door (Weeping Angel Version) Only The Lonely (Sirens RMX)
Only The Lonely (Sirens RMX) Sweet Virginia
Sweet Virginia Hey Jude
Hey Jude Black Magic Woman
Black Magic Woman I'm So Lonesome I Could Cry
I'm So Lonesome I Could Cry Rubber Duckie
Rubber Duckie Telstar
Telstar Don't Stop
Don't Stop How To Disappear Completely (Tired RMX)
How To Disappear Completely (Tired RMX) Die Mensch-Machine
Die Mensch-Machine Dreams
Dreams Mind Games
Mind Games You Make Loving Fun
You Make Loving Fun Jesu Joy Of Man's Desiring
Jesu Joy Of Man's Desiring Rhiannon
Rhiannon Xmas Bells (Ukraine)
Xmas Bells (Ukraine) Little Lies
Little Lies Songbird (Extended RMX)
Songbird (Extended RMX) Say You Love Me (Wendy RMX)
Say You Love Me (Wendy RMX) Go Your Own Way
Go Your Own Way Worried Man
Worried Man The Bends
The Bends Flash
Flash Salve Radix [The Rose Canon]
Salve Radix [The Rose Canon] Stop Whispering
Stop Whispering Seven Zero
Seven Zero White Shadows
White Shadows Cruel Summer
Cruel Summer All I Need
All I Need Kailash
Kailash Besame Mucho
Besame Mucho Codex
Codex Lachrimae
Lachrimae Fantaisie-Impromptu
Fantaisie-Impromptu Tumbling Dice
Tumbling Dice Stormy Monday
Stormy Monday Go To Sleep
Go To Sleep Sadeness
Sadeness Brazil
Brazil How I Made My Millions
How I Made My Millions Baby Blue
Baby Blue Die Another Day (Profane RMX)
Die Another Day (Profane RMX) Catch The Wind
Catch The Wind Star Trek
Star Trek November Rain
November Rain Stardust
Stardust Steam
Steam The World Is Not Enough (Redux)
The World Is Not Enough (Redux) They Call Me The Breeze
They Call Me The Breeze And You And I
And You And I Africa
Africa Clocks
Clocks Crazy Little Thing Called Love
Crazy Little Thing Called Love Pick Up The Pieces
Pick Up The Pieces She Blinded Me With Science
She Blinded Me With Science Pop Is Dead
Pop Is Dead Hot Stuff
Hot Stuff Jerusalem
Jerusalem Boombastic
Boombastic Govindam
Govindam Mission Impossible (Durga Temple RMX)
Mission Impossible (Durga Temple RMX) Just (Stinky Version)
Just (Stinky Version) Tales Of Brave Ulysses
Tales Of Brave Ulysses Her Majesty
Her Majesty Here Comes The Sun
Here Comes The Sun Skyfall
Skyfall Lovesong
Lovesong Paperback Writer
Paperback Writer Got To Get You Into My Life
Got To Get You Into My Life I'm Only Sleeping
I'm Only Sleeping Goodbye Yellow Brick Road
Goodbye Yellow Brick Road Whole Lotta Shakin' Goin' On
Whole Lotta Shakin' Goin' On Bangers And Mash
Bangers And Mash Yellow
Yellow Something So Strong
Something So Strong Watching The Wheels Go By
Watching The Wheels Go By Fake Plastic Trees (ISS Version)
Fake Plastic Trees (ISS Version) No Woman No Cry
No Woman No Cry Around The World
Around The World You Only Live Twice
You Only Live Twice Bodysnatchers
Bodysnatchers Bulletproof
Bulletproof Sulk
Sulk I Might Be Wrong [Voice Box Version]
I Might Be Wrong [Voice Box Version] High & Dry [Voice Box Version]
High & Dry [Voice Box Version] Let Down [Voice Box Version]
Let Down [Voice Box Version] The Ipcress File
The Ipcress File Deserted Cities Of The Heart
Deserted Cities Of The Heart She Came In Through The Bathroom Window
She Came In Through The Bathroom Window Sunshine Of Your Love
Sunshine Of Your Love Where I End And You Begin
Where I End And You Begin Moon River
Moon River Ripcord
Ripcord Du Hast
Du Hast Trans-Europe Express
Trans-Europe Express The Ragpicker's Dream
The Ragpicker's Dream Sultans Of Swing
Sultans Of Swing Up On The Roof
Up On The Roof Cry Baby Cry
Cry Baby Cry Spectral Mornings
Spectral Mornings I Feel Love
I Feel Love Endless Love
Endless Love Radar Love
Radar Love Big-time Sensuality
Big-time Sensuality Honky Tonk Women
Honky Tonk Women Born Under A Bad Sign (T-Bone Version)
Born Under A Bad Sign (T-Bone Version) All You Need Is Love
All You Need Is Love New Born
New Born Morning Bell (Bellicose Version)
Morning Bell (Bellicose Version) (Nice Dream)
(Nice Dream) Key To The Highway
Key To The Highway I Want You (She's So Heavy) [XTD Version]
I Want You (She's So Heavy) [XTD Version] I Want You (She's So Heavy)
I Want You (She's So Heavy) Rain
Rain Blue Sky Mine
Blue Sky Mine Can't Find My Way Home
Can't Find My Way Home The Middle
The Middle Nivram
Nivram Unchained Melody
Unchained Melody Kontiki
Kontiki The Savage
The Savage Building The Church
Building The Church Botany Bay
Botany Bay Deutschlandlied
Deutschlandlied My Happiness
My Happiness What You Need
What You Need The Song Of Australia
The Song Of Australia A Pub With No Beer
A Pub With No Beer Apache (Redux)
Apache (Redux) Choir Girl
Choir Girl God Save The King
God Save The King On Her Majesty's Secret Service
On Her Majesty's Secret Service Fall Dog Bombs The Moon
Fall Dog Bombs The Moon Elephant (Redux)
Elephant (Redux) Requiem in D Minor, K 626: 7. Agnes Dei, 8. Communio
Requiem in D Minor, K 626: 7. Agnes Dei, 8. Communio Requiem in D Minor, K 626: 1. Introitus
Requiem in D Minor, K 626: 1. Introitus The Wild Colonial Boy
The Wild Colonial Boy If Not For You
If Not For You Into The Mystic
Into The Mystic Rawhide
Rawhide The Lone Ranger (Redux)
The Lone Ranger (Redux) William Tell (Overture)
William Tell (Overture) Perry Mason
Perry Mason Australia
Australia Motorcycle Emptiness
Motorcycle Emptiness Ghost Riders In The Sky
Ghost Riders In The Sky Atlantis
Atlantis I Want None Of This
I Want None Of This Goldfinger
Goldfinger Drive My Car
Drive My Car I Can See For Miles
I Can See For Miles Take The Long Way Home
Take The Long Way Home Peace
Peace Blow The Man Down
Blow The Man Down Nobody Does It Better
Nobody Does It Better Beds Are Burning
Beds Are Burning The Unforgiven
The Unforgiven BWV 1043 Concerto For Two Violins, Andante
BWV 1043 Concerto For Two Violins, Andante Verstohlen geht der Mond auf
Verstohlen geht der Mond auf The Voice
The Voice The Less I Know The Better
The Less I Know The Better I Will Sing My Maker's Praises
I Will Sing My Maker's Praises The Black Forest
The Black Forest Oberek
Oberek The Colony
The Colony The Three Ravens
The Three Ravens Flowers Of The Forest
Flowers Of The Forest The Ocean
The Ocean Becalmed
Becalmed The Lancers Set
The Lancers Set Die Mazurka des Skjold
Die Mazurka des Skjold Bound For South Australia
Bound For South Australia Hamburg
Hamburg Berlin
Berlin The Barges
The Barges Lamentation
Lamentation Fleeing Oppression
Fleeing Oppression Hedwig's Peal
Hedwig's Peal Wender
Wender Trilogy
Trilogy Electric Ladyland
Electric Ladyland Neutron Dance
Neutron Dance Run Through The Jungle
Run Through The Jungle You've Got To Hide Your Love Away
You've Got To Hide Your Love Away 1999
1999 This Is Not America
This Is Not America You and Who's Army?
You and Who's Army? 1979
1979 DUNE
DUNE All The Small Things
All The Small Things Closer
Closer Head Like A Hole
Head Like A Hole The Perfect Drug
The Perfect Drug Enter Sandman
Enter Sandman A Forest
A Forest Fascination Street
Fascination Street World In My Eyes
World In My Eyes Despacito
Despacito Just Like Heaven
Just Like Heaven Man Of War
Man Of War Big Boots (Man Of War)
Big Boots (Man Of War) Westworld
Westworld Freedom
Freedom Take A Pebble
Take A Pebble Talk Show Host
Talk Show Host Aeroplane
Aeroplane (I've seen) All Good People
(I've seen) All Good People I Go To Rio
I Go To Rio Street Spirit
Street Spirit Dear Prudence
Dear Prudence The National Anthem
The National Anthem Blade Runner
Blade Runner Present Tense
Present Tense Sail To The Moon
Sail To The Moon Good Lovin'
Good Lovin' Idioteque
Idioteque Rikki Don't Lose That Number
Rikki Don't Lose That Number Let Down
Let Down Pyramid Song
Pyramid Song Black
Black Inception
Inception Popcorn
Popcorn Little Wing (Reduxed)
Little Wing (Reduxed) I Will
I Will The Rise and Fall of Flingel Bunt
The Rise and Fall of Flingel Bunt Jeepster
Jeepster Sirtaki
Sirtaki Heroes
Heroes Jin-Go
Jin-Go Bold As Love
Bold As Love Good Vibrations
Good Vibrations Kokomo
Kokomo Black Star (Resilient RMX)
Black Star (Resilient RMX) Nantucket Sleighride
Nantucket Sleighride Sofa No. 3
Sofa No. 3 Souvenir de Chine
Souvenir de Chine Optimistic (Jurassic RMX)
Optimistic (Jurassic RMX) Scatterbrain
Scatterbrain Life In A Glass House #2
Life In A Glass House #2 Diva Dance
Diva Dance The Fifth Element Theme
The Fifth Element Theme Because The Night
Because The Night We Belong
We Belong Shadows Of The Night
Shadows Of The Night She's A Rainbow
She's A Rainbow A Man Without Love
A Man Without Love Fremdling
Fremdling Fremdling (Part 1)
Fremdling (Part 1) Fremdling (Part 2)
Fremdling (Part 2) Under The Boardwalk [Redux]
Under The Boardwalk [Redux] When The Levee Breaks
When The Levee Breaks The Numbers
The Numbers Nude
Nude Sommernachtstraum und Begleitmusik (Part 2)
Sommernachtstraum und Begleitmusik (Part 2) Bad Boy
Bad Boy Sommernachtstraum und Begleitmusik [Part 1]
Sommernachtstraum und Begleitmusik [Part 1] California Dreaming
California Dreaming Concerto in A minor for Four Harpsichords, BWV 1065
Concerto in A minor for Four Harpsichords, BWV 1065 China Girl
China Girl Orchestral Suite No. 3 in D Major, BWV 1068 [2nd Movement]
Orchestral Suite No. 3 in D Major, BWV 1068 [2nd Movement] I Am The Walrus (Xpert RMX)
I Am The Walrus (Xpert RMX) Roll Over Beethoven
Roll Over Beethoven Clarinet Concerto in A Major, K. 622
Clarinet Concerto in A Major, K. 622 Symphony No. 5 [1st Movement: Allegro con brio]
Symphony No. 5 [1st Movement: Allegro con brio] I Might Be Wrong (For Lviv)
I Might Be Wrong (For Lviv) Cosmic Love
Cosmic Love (Just Like) Spinning Plates
(Just Like) Spinning Plates Sail Away
Sail Away Sailing
Sailing Bohemian Rhapsody
Bohemian Rhapsody My Iron Lung
My Iron Lung Hurts So Good
Hurts So Good Kashmir
Kashmir Let My Love Open The Door
Let My Love Open The Door Dust In The Wind
Dust In The Wind The Reflex
The Reflex Living Sin
Living Sin Zebra
Zebra You Never Wash Up After Yourself
You Never Wash Up After Yourself All The Things You Are
All The Things You Are Ukranian National Anthem (Grey Wolf RMX)
Ukranian National Anthem (Grey Wolf RMX) La Vie En Rose
La Vie En Rose Personal Jesus (Pantocrator RMX)
Personal Jesus (Pantocrator RMX) Peggy Sue
Peggy Sue Polyethylene [Parts 1 & 2]
Polyethylene [Parts 1 & 2] I Am The Walrus
I Am The Walrus Die Another Day
Die Another Day The Young Ones
The Young Ones Surf Rider
Surf Rider Ride Like The Wind
Ride Like The Wind Fanfare For The Common Man
Fanfare For The Common Man What You Need
What You Need Mission: Impossible Theme
Mission: Impossible Theme Ukraine: National Anthem
Ukraine: National Anthem Exit Music (For A Film)
Exit Music (For A Film) Karma Police
Karma Police A Whiter Shade Of Pale (Synesthesia RMX)
A Whiter Shade Of Pale (Synesthesia RMX) A Whiter Shade Of Pale (Resurrection RMX)
A Whiter Shade Of Pale (Resurrection RMX) A Whiter Shade Of Pale
A Whiter Shade Of Pale Jigsaw Falling Into Place
Jigsaw Falling Into Place A Night Like This
A Night Like This Lotus Flower
Lotus Flower Tarkus (Part 2)
Tarkus (Part 2) Tarkus (Part 1)
Tarkus (Part 1) Rock 'n' Roll High School
Rock 'n' Roll High School Mazurka in GM, [Opus 50, No. 1]
Mazurka in GM, [Opus 50, No. 1] Neon Lights
Neon Lights Paranoid Android
Paranoid Android Awake Sweet Love [thou art returned]
Awake Sweet Love [thou art returned] Item de Virginibus (Redux)
Item de Virginibus (Redux) Optimistic
Optimistic Fugue in CM [Hess 236, No. 9]
Fugue in CM [Hess 236, No. 9] Touch And Go
Touch And Go Autobahn (Roadtrain RMX)
Autobahn (Roadtrain RMX) Wolf At The Door
Wolf At The Door Handle With Care
Handle With Care Fly Me To The Moon [In Other Words]
Fly Me To The Moon [In Other Words] Runaway
Runaway Fake Plastic Trees
Fake Plastic Trees Born Slippy [NUXX]
Born Slippy [NUXX] God Only Knows (Resilient RMX)
God Only Knows (Resilient RMX) Please Don't Go
Please Don't Go Time (Omicron RMX)
Time (Omicron RMX) Boom, Boom, Boom, Boom
Boom, Boom, Boom, Boom If Not For You
If Not For You Mystify
Mystify High And Dry
High And Dry Birthday
Birthday Oh Yoko!
Oh Yoko! Gimme Shelter
Gimme Shelter Inception
Inception 4 Minute Warning
4 Minute Warning Highland Fairy Lullaby
Highland Fairy Lullaby Instant Karma (Redux)
Instant Karma (Redux) The Land Down Under
The Land Down Under Wipeout
Wipeout Starship Trooper
Starship Trooper Midnight Rambler (Kitchen Door RMX)
Midnight Rambler (Kitchen Door RMX) Time Is On My Side
Time Is On My Side Reckoner (Ready RMX)
Reckoner (Ready RMX) Lucky (Plan 9 Western RMX)
Lucky (Plan 9 Western RMX) Walking The Dog
Walking The Dog Close To The Edge
Close To The Edge C.C. Rider
C.C. Rider Reelin' In The Years
Reelin' In The Years From Russia With Love
From Russia With Love Das wohltemperierte Klavier II, BWV 870
Das wohltemperierte Klavier II, BWV 870 Videotape
Videotape Blow Out
Blow Out Killing Me Softly
Killing Me Softly Peter and The Wolf
Peter and The Wolf Peter and The Wolf (Part 2)
Peter and The Wolf (Part 2) Peter and The Wolf (Part 1)
Peter and The Wolf (Part 1) Nothing Else Matters
Nothing Else Matters Misirlou
Misirlou Rumble
Rumble Motion Picture Soundtrack
Motion Picture Soundtrack The Expanse 2
The Expanse 2 Must Be Santa
Must Be Santa In The End
In The End Witchy Woman
Witchy Woman Lucky Man
Lucky Man The Bends
The Bends Peaceful Easy Feeling
Peaceful Easy Feeling Don't Fear The Reaper (Redux)
Don't Fear The Reaper (Redux) Take It Easy (Borg RMX)
Take It Easy (Borg RMX) Every Little Thing
Every Little Thing Bodysnatchers
Bodysnatchers Ain't She Sweet
Ain't She Sweet A Groovy Kind Of Love
A Groovy Kind Of Love Surf Rider
Surf Rider How Bizarre
How Bizarre Chor Credo In Unum Deum
Chor Credo In Unum Deum A Question Of Lust
A Question Of Lust Year Of The Cat
Year Of The Cat Sitting On Top Of The World (Bolton RMX)
Sitting On Top Of The World (Bolton RMX) Sitting On Top Of The World (Redux)
Sitting On Top Of The World (Redux) Black Is The Colour Of My True Love's Hair
Black Is The Colour Of My True Love's Hair Street Spirit
Street Spirit Only The Lonely
Only The Lonely White Rabbit
White Rabbit (Like) Spinning Plates
(Like) Spinning Plates Big Love
Big Love End Of The Line
End Of The Line Psalm 69
Psalm 69 Wishing Well
Wishing Well Let There Be Drums '21 (Delta RMX)
Let There Be Drums '21 (Delta RMX) No Time To Die (Redux)
No Time To Die (Redux) Heart-Shaped Box
Heart-Shaped Box Say You Love Me
Say You Love Me New Born
New Born Interstellar (Redux)
Interstellar (Redux) Supermassive Black Hole
Supermassive Black Hole Doctor Who (Redux)
Doctor Who (Redux) Welcome To The Machine
Welcome To The Machine True Faith
True Faith Sweet Jane
Sweet Jane So-me-thing
So-me-thing Wonderful Life
Wonderful Life This Is The One [Welcome Home RMX]
This Is The One [Welcome Home RMX] (Song For My) Sugar Spun Sister
(Song For My) Sugar Spun Sister I'm On Fire
I'm On Fire The Mighty Quinn (Quinn the Eskimo)
The Mighty Quinn (Quinn the Eskimo) Here Comes Your Man
Here Comes Your Man Can You [Point Your Fingers and Do The Twist]
Can You [Point Your Fingers and Do The Twist] Too Many People
Too Many People Can't Find My Way Home
Can't Find My Way Home Walking In My Shoes (Delta RMX)
Walking In My Shoes (Delta RMX) Hideaway
Hideaway Subterranean Homesick Alien
Subterranean Homesick Alien In The End
In The End The Norefjell Theme
The Norefjell Theme Reckoner
Reckoner Exit Music [For A Film]
Exit Music [For A Film] In My Life (Transfixed RMX)
In My Life (Transfixed RMX) Nothing As It Seems
Nothing As It Seems Guns Of Brixton
Guns Of Brixton Mission Impossible Theme
Mission Impossible Theme Wayfaring Stranger
Wayfaring Stranger Echoes
Echoes The Power Of Love
The Power Of Love Venus
Venus Wrong Number
Wrong Number There There
There There Punch Up At A Wedding (Broken RMX)
Punch Up At A Wedding (Broken RMX) Loops Of Fury
Loops Of Fury I Run Away
I Run Away Fantasy
Fantasy This Strange Effect
This Strange Effect Sour Times
Sour Times Dancing Days (How The West Was Won)
Dancing Days (How The West Was Won) Badge
Badge How Beautiful You Are (Inspiration4 RMX)
How Beautiful You Are (Inspiration4 RMX) Silent Lucidity (Delta RMX)
Silent Lucidity (Delta RMX) The Windjammer
The Windjammer The World Is Not Enough
The World Is Not Enough Brown Sugar
Brown Sugar Everything In It's Right Place (Delta RMX)
Everything In It's Right Place (Delta RMX) Torn
Torn Down Is The New Up
Down Is The New Up Born Under A Bad Sign (Delta RMX)
Born Under A Bad Sign (Delta RMX) Got To Get Better In A Little While
Got To Get Better In A Little While Cherry Bomb
Cherry Bomb I Think I'm Paranoid (Delta RMX)
I Think I'm Paranoid (Delta RMX) Goin' Up The Country (Redux)
Goin' Up The Country (Redux) Black Star (Delta RMX)
Black Star (Delta RMX) Under Pressure (Delta RMX)
Under Pressure (Delta RMX) Watermelon In Easter Hay (Delta RMX)
Watermelon In Easter Hay (Delta RMX) White Room
White Room Planet Telex
Planet Telex Redemption Song
Redemption Song Shout To The Top!
Shout To The Top! Tell Me
Tell Me Life In A Glass House
Life In A Glass House Cocaine
Cocaine Moby Dick
Moby Dick Born Slippy .NUXX (Delta RMX)
Born Slippy .NUXX (Delta RMX) Going To California (Delta RMX)
Going To California (Delta RMX) I Might Be Wrong (Delta RMX)
I Might Be Wrong (Delta RMX) Cold Cold Heart
Cold Cold Heart Get It On
Get It On Take On Me
Take On Me Astral Traveller
Astral Traveller Little Martha
Little Martha Statesboro Blues (Delta RMX)
Statesboro Blues (Delta RMX) Melissa
Melissa For No One
For No One One Of These Days
One Of These Days Elephant
Elephant Foolin'
Foolin' Round And Around (Delta RMX)
Round And Around (Delta RMX) Photograph
Photograph Riders On The Storm
Riders On The Storm Billy's Got A Gun
Billy's Got A Gun Climbing Up The Walls (Delta RMX)
Climbing Up The Walls (Delta RMX) Never Tear Us Apart
Never Tear Us Apart I Saved The World Today
I Saved The World Today No More I Love You's
No More I Love You's This Is The One (Delta RMX)
This Is The One (Delta RMX) Everlong
Everlong I Wanna Be Adored (Delta RMX)
I Wanna Be Adored (Delta RMX) Made Of Stone
Made Of Stone It's All Over Now
It's All Over Now 19th Nervous Breakdown
19th Nervous Breakdown You Can't Always Get What You Want
You Can't Always Get What You Want Mothers Little Helper
Mothers Little Helper Get Off My Cloud
Get Off My Cloud Midnight Rambler
Midnight Rambler Stitch
Stitch
 Call It Stormy Monday (But Tuesday Is Just As Bad)
Call It Stormy Monday (But Tuesday Is Just As Bad) Love (on the) Rocks
Love (on the) Rocks Pop Corn
Pop Corn Idioteque (Redux)
Idioteque (Redux) The World Is A Ghetto
The World Is A Ghetto Can't Get Enough Of You Baby
Can't Get Enough Of You Baby Livin' Da Vida Loca
Livin' Da Vida Loca Bad Boys
Bad Boys Messenjah
Messenjah Red Red Wine
Red Red Wine Things Can Only Get Better
Things Can Only Get Better Redemption Song
Redemption Song Exodus
Exodus I Can See Clearly Now
I Can See Clearly Now Higher Ground
Higher Ground The Things We Do For Love
The Things We Do For Love Nothing Too Serious
Nothing Too Serious Dreadlock Holiday
Dreadlock Holiday Jet
Jet Revolutions
Revolutions Strange Ways
Strange Ways Friday I'm In Love
Friday I'm In Love Stumblin' In
Stumblin' In Ziggy Stardust
Ziggy Stardust Hot Love
Hot Love Perfect Day
Perfect Day Suspicious Minds
Suspicious Minds Twentieth Century Boy
Twentieth Century Boy Vanish Into You
Vanish Into You Ziggy Stardust
Ziggy Stardust Can The Can
Can The Can Nothing's Gonna Stop Us Now
Nothing's Gonna Stop Us Now Ballroom Blitz
Ballroom Blitz Jump
Jump Rebel Rebel
Rebel Rebel Tubular Bells
Tubular Bells Killer Queen
Killer Queen Golden Eye
Golden Eye Cum Feel The Noize
Cum Feel The Noize You Give Love A Bad Name
You Give Love A Bad Name Virginia Plain
Virginia Plain Only The Good Die Young
Only The Good Die Young All The Young Dudes
All The Young Dudes Mission Impossible
Mission Impossible Licence To Kill
Licence To Kill Jumpin' Jack Flash
Jumpin' Jack Flash I Believe In A Thing Called Love
I Believe In A Thing Called Love Electric Cafe
Electric Cafe Shout
Shout She Came In Through The Bathroom Window
She Came In Through The Bathroom Window Highway To Hell
Highway To Hell Too Many People
Too Many People The Man-Machine
The Man-Machine Blow Out
Blow Out Meglomania
Meglomania Behind Blue Eyes
Behind Blue Eyes Bell Bottom Blues
Bell Bottom Blues Over, Under, Sideways, Down
Over, Under, Sideways, Down Under My Thumb
Under My Thumb Endlessly
Endlessly Gallows Pole
Gallows Pole The Battle of Evermore
The Battle of Evermore For Your Eyes Only
For Your Eyes Only Back In Black
Back In Black Alter Ego
Alter Ego White Bird
White Bird In Your World
In Your World Hungarian Rhapsody No. 2 in C# Minor, S.244/2
Hungarian Rhapsody No. 2 in C# Minor, S.244/2 Get Up, Stand Up
Get Up, Stand Up Undisclosed Desires
Undisclosed Desires Voyager
Voyager Happy Trails
Happy Trails Without You
Without You Can't Take My Eyes Off Of You
Can't Take My Eyes Off Of You Black Dog
Black Dog Falling Down
Falling Down When The Levee Breaks
When The Levee Breaks Jesus bleibet meine Freude, BWV 147
Jesus bleibet meine Freude, BWV 147 Wild Is The Wind
Wild Is The Wind Lovely Rita
Lovely Rita Kid A
Kid A Hysteria (Redux)
Hysteria (Redux) America
America Endless Enigma [Part One]
Endless Enigma [Part One] Da Funk
Da Funk Cult
Cult Robot Rock
Robot Rock Unintended
Unintended Crippled Inside
Crippled Inside Mind Games
Mind Games Nights In White Satin
Nights In White Satin John Barleycorn (Must Die)
John Barleycorn (Must Die) All Time High
All Time High Do It Again
Do It Again Piano Man
Piano Man Dig Down
Dig Down When The Levee Breaks
When The Levee Breaks Everyday People
Everyday People Sky Pilot
Sky Pilot Setting Sun
Setting Sun The National Anthem (Again)
The National Anthem (Again) Thought Contagion
Thought Contagion Dedicated Follower Of Fashion
Dedicated Follower Of Fashion Baker Street
Baker Street Let My Love Open The Door
Let My Love Open The Door Force Majeure
Force Majeure I Still Call Australia Home
I Still Call Australia Home Shine On You Crazy Diamond
Shine On You Crazy Diamond The Kids Are Alright
The Kids Are Alright Big Boots
Big Boots Rain On Me
Rain On Me Daydreaming
Daydreaming Hey Joe
Hey Joe Moth Into Flame
Moth Into Flame Day After Day
Day After Day Baby Blue
Baby Blue Paparazzi
Paparazzi Liberation
Liberation In Your World
In Your World MK Ultra
MK Ultra Eyes Without A Face
Eyes Without A Face Sail To The Moon [with the Owl & the Pussycat]
Sail To The Moon [with the Owl & the Pussycat] Just Dance
Just Dance Born This Way
Born This Way Band On The Run
Band On The Run You Never Give Me Your Money
You Never Give Me Your Money Dolphin Dance
Dolphin Dance Stuntman
Stuntman Time
Time Girls Just Wanna Have Fun
Girls Just Wanna Have Fun Real Love
Real Love Baby Don't Cry
Baby Don't Cry Micro Cuts
Micro Cuts Aurora
Aurora Packt Like Sardines In a Crushd Tin Box
Packt Like Sardines In a Crushd Tin Box Problem
Problem Dead Inside
Dead Inside Mars The Bringer Of War
Mars The Bringer Of War Light My Fire
Light My Fire Flash (Rewound)
Flash (Rewound) Genesis Ch.1 Vs. 32
Genesis Ch.1 Vs. 32 Renegades Of Funk
Renegades Of Funk Guerrilla Radio
Guerrilla Radio Citizen Erased
Citizen Erased Eternal Flame
Eternal Flame The King Of Denmark's Galliard (LOST reMASTER)
The King Of Denmark's Galliard (LOST reMASTER) We Are Never Ever Getting Back Together (LOST reMASTER)
We Are Never Ever Getting Back Together (LOST reMASTER) Plug In Baby! (LOST reMASTER)
Plug In Baby! (LOST reMASTER) Beat It! (LOST reMaster)
Beat It! (LOST reMaster) Hash Pipe
Hash Pipe Muscle Museum
Muscle Museum Paradise
Paradise Harder Better Faster Stronger
Harder Better Faster Stronger Love Will Tear Us Apart
Love Will Tear Us Apart Kaleid
Kaleid Blackstar
Blackstar Knife-Edge
Knife-Edge How Deep Is Your Love
How Deep Is Your Love Enter Sandman (Again)
Enter Sandman (Again) Islands In The Stream
Islands In The Stream Monkberry Moon Delight (Redux)
Monkberry Moon Delight (Redux) All Along The Watchtower
All Along The Watchtower Teardrop
Teardrop Summertime Blues
Summertime Blues Feel Good Inc.
Feel Good Inc. Alter Ego
Alter Ego Won't Get Fooled Again
Won't Get Fooled Again Devil In Disguise
Devil In Disguise High & Dry (Broken Bank Edition)
High & Dry (Broken Bank Edition) Itchycoo Park
Itchycoo Park An Innocent Man
An Innocent Man Born Slippy [Untimely Ripped]
Born Slippy [Untimely Ripped] My Sharona
My Sharona Starlight
Starlight Pictures Of Lily
Pictures Of Lily Baba O'Riley
Baba O'Riley Savoy Truffle
Savoy Truffle Pumped Up Kicks
Pumped Up Kicks The Middle
The Middle Uprising
Uprising Long Tall Sally
Long Tall Sally Yes It Is
Yes It Is Like A Rolling Stone (Redux)
Like A Rolling Stone (Redux) She Sells Sanctuary
She Sells Sanctuary Mad World
Mad World Regret
Regret The Kids Are Alright
The Kids Are Alright Born To Be Wild
Born To Be Wild Running Bear
Running Bear Eye Of The Tiger
Eye Of The Tiger Teddy Bear
Teddy Bear Baby Elephant Walk
Baby Elephant Walk The Lion Sleeps Tonight
The Lion Sleeps Tonight Us And Them (Redux)
Us And Them (Redux) Missing You
Missing You Kiss Me
Kiss Me Bach: Partita in D Minor, BWV 1004: 5. Chaconne.
Bach: Partita in D Minor, BWV 1004: 5. Chaconne. Fearless
Fearless When Doves Cry
When Doves Cry Eminence Front
Eminence Front Roundabout
Roundabout Schubert: Rondo brilliant in B Minor, Op. 70, D. 895
Schubert: Rondo brilliant in B Minor, Op. 70, D. 895 C'est La Vie
C'est La Vie Saturnz Barz (Spirit House)
Saturnz Barz (Spirit House) Tender
Tender What Do You Want From Me (Redux)
What Do You Want From Me (Redux) Smells Like Teen Spirit
Smells Like Teen Spirit Main Title/Trinity Infinity [From 'The Matrix']
Main Title/Trinity Infinity [From 'The Matrix'] Atom Heart Mother
Atom Heart Mother Funkytown
Funkytown Grosse Fuge
Grosse Fuge Inbetween Days
Inbetween Days Venus
Venus Shout
Shout The Numbers (2024 Edition)
The Numbers (2024 Edition) Bad To Me
Bad To Me Inside My Head (Redux)
Inside My Head (Redux) Europa
Europa Oye Como Va
Oye Como Va Samba Pa Ti
Samba Pa Ti Thriller
Thriller Walk Right Back (Redux)
Walk Right Back (Redux) Everybody's Everything
Everybody's Everything Siberian Khatru
Siberian Khatru Close To The Edge
Close To The Edge Dirty Love
Dirty Love Heart Of The Sunrise
Heart Of The Sunrise I've Seen All Good People
I've Seen All Good People Forever Young
Forever Young Good Riddance
Good Riddance We Have All The Time In The World
We Have All The Time In The World Mozart: Requiem, in Dm, K.626: No. 12
Mozart: Requiem, in Dm, K.626: No. 12 That Don't Impress Me Much
That Don't Impress Me Much Peaches en Regalia
Peaches en Regalia Sunburn
Sunburn Only Women Bleed
Only Women Bleed Jump In The Line
Jump In The Line Mozart: Requiem in Dm, K. 626: No. 12
Mozart: Requiem in Dm, K. 626: No. 12 Echoes
Echoes Stockholm Syndrome
Stockholm Syndrome Breathe
Breathe Ace Of Spades
Ace Of Spades I Won't Back Down
I Won't Back Down The Wind Cries Mary
The Wind Cries Mary Personal Jesus (Redux)
Personal Jesus (Redux) Stone Free
Stone Free Hurt
Hurt Fly Me To The Moon
Fly Me To The Moon Golden Brown
Golden Brown Ghostbusters
Ghostbusters The Last Starfighter
The Last Starfighter Paparazzi
Paparazzi What Time Is Love?
What Time Is Love? All That She Wants
All That She Wants Hysteria
Hysteria Don't Worry Baby
Don't Worry Baby Hotel California
Hotel California Beethoven: Piano Sonata No. 14
Beethoven: Piano Sonata No. 14 Wonderwall
Wonderwall Rip It Up
Rip It Up Torn (again)
Torn (again) Never Tear Us Apart (Redux)
Never Tear Us Apart (Redux) Pearly
Pearly House Of Cards
House Of Cards Mozart: Serenade [No. 13] in G Major for string orchestra, K 525 (Eine kleine Nachtmusik) - Movement No. 2, Andante.
Mozart: Serenade [No. 13] in G Major for string orchestra, K 525 (Eine kleine Nachtmusik) - Movement No. 2, Andante. Mozart: Serenade [No. 13] in G Major for string orchestra, K 525 (Eine kleine Nachtmusik) - Movement No. 1, Allegro.
Mozart: Serenade [No. 13] in G Major for string orchestra, K 525 (Eine kleine Nachtmusik) - Movement No. 1, Allegro. Push It
Push It Bodysnatchers
Bodysnatchers Inca Roads
Inca Roads Smoke On The Water
Smoke On The Water Paranoid
Paranoid (Thinking about) Last Night
(Thinking about) Last Night Never Gonna Give You Up
Never Gonna Give You Up (Red Hot) Higher Ground
(Red Hot) Higher Ground Take It Easy
Take It Easy Concerto For Two Violins in Dm BMV 1043
Concerto For Two Violins in Dm BMV 1043 On The Turning Away
On The Turning Away Beautiful Boy
Beautiful Boy Beethoven: Piano Sonata No. 30, Op. 109
Beethoven: Piano Sonata No. 30, Op. 109 True
True What's Love Got To Do With It
What's Love Got To Do With It World In My Eyes
World In My Eyes Higher Ground
Higher Ground Fly
Fly Everything's Alright
Everything's Alright Jerusalem (Unbound)
Jerusalem (Unbound) Superstition
Superstition You Can Get It If You Really Want
You Can Get It If You Really Want Doggie In The Window
Doggie In The Window Epitaph
Epitaph Walk Like An Egyptian
Walk Like An Egyptian Push The Button
Push The Button Banana Co. (Redux)
Banana Co. (Redux) Glass Eyes
Glass Eyes Bishop's Robes
Bishop's Robes Decks Dark
Decks Dark Beethoven: Symphony No. 3 in Eb Major (Eroica). IV. Finale. Allegro molto – Poco
Beethoven: Symphony No. 3 in Eb Major (Eroica). IV. Finale. Allegro molto – Poco Beethoven: Symphony No. 3 in Eb Major (Eroica) - II. Marcia funebre. Adagio assai
Beethoven: Symphony No. 3 in Eb Major (Eroica) - II. Marcia funebre. Adagio assai Beethoven: Symphony No. 3 in Eb Major (Eroica). III. Scherzo. Allegro vivace – Trio
Beethoven: Symphony No. 3 in Eb Major (Eroica). III. Scherzo. Allegro vivace – Trio Beethoven: Symphony No. 3 in Eb Major (Eroica) - I. Allegro con brio
Beethoven: Symphony No. 3 in Eb Major (Eroica) - I. Allegro con brio The Robots
The Robots Set The Controls (For The Heart Of The Sun)
Set The Controls (For The Heart Of The Sun) Anyone Can Play Guitar
Anyone Can Play Guitar Gold
Gold The Yellow Rose (Of Texas)
The Yellow Rose (Of Texas) Yellow
Yellow Jennifer Juniper
Jennifer Juniper The Season Of The Witch
The Season Of The Witch Copland: Fanfare For The Common Man
Copland: Fanfare For The Common Man Feeling Good
Feeling Good True Love Waits [next in line]
True Love Waits [next in line] Fake Plastic Trees [pre-fab assemblage]
Fake Plastic Trees [pre-fab assemblage] Mussorgsky: Pictures At An Exhibition - The Gnome
Mussorgsky: Pictures At An Exhibition - The Gnome Lucky Man
Lucky Man I Am Citizen Insane
I Am Citizen Insane Like A Rolling Stone
Like A Rolling Stone Paperbag Writer
Paperbag Writer Subterranean Homesick Blues
Subterranean Homesick Blues Sweet Home Alabama
Sweet Home Alabama Call Me The Breeze
Call Me The Breeze Mellow Yellow
Mellow Yellow Sunshine Superman
Sunshine Superman The Fool On The Hill
The Fool On The Hill I'm Down
I'm Down How Soon Is Now?
How Soon Is Now? Hand In Glove
Hand In Glove This Charming Man
This Charming Man The Terminator
The Terminator A Night Like This
A Night Like This Lovesong
Lovesong I'll Cry Instead
I'll Cry Instead J.S. Bach: Sonata for Solo Guitar No. 1 in G Minor, BWM 1001
J.S. Bach: Sonata for Solo Guitar No. 1 in G Minor, BWM 1001 A Hard Day's Night
A Hard Day's Night Sultans Of Swing
Sultans Of Swing JMJ Medley
JMJ Medley Sit Down, Stand Up
Sit Down, Stand Up Peter Gunn
Peter Gunn Let It Happen
Let It Happen From The Beginning
From The Beginning All Out Of Love
All Out Of Love The Naked Gun
The Naked Gun Shaft
Shaft Axel F
Axel F Don't You (Forget About Me)
Don't You (Forget About Me) Antarctica
Antarctica Holiday
Holiday Elephant-ine
Elephant-ine Flying
Flying Galaxy Quest
Galaxy Quest Bad Guy
Bad Guy As Long As I Can See The Light
As Long As I Can See The Light Pretty Fly (For A White Guy)
Pretty Fly (For A White Guy) Seven Wonders
Seven Wonders All Time High
All Time High Take On Me
Take On Me Photograph
Photograph Codex
Codex Happy Christmas [War Is Over]
Happy Christmas [War Is Over] Bloom
Bloom Christmas Carols
Christmas Carols Mozart: Clarinet Quintet
Mozart: Clarinet Quintet In My Life
In My Life Can't Find My Way Home
Can't Find My Way Home Dear Mr Fantasy
Dear Mr Fantasy Brazil
Brazil Lightning Crashes
Lightning Crashes Wonderful Land
Wonderful Land I Can See For Miles
I Can See For Miles Abracadabra
Abracadabra I'm A Man
I'm A Man Lucky Lips
Lucky Lips (Baby I've Got You) On My Mind
(Baby I've Got You) On My Mind Passenger
Passenger Please Please Me
Please Please Me S.O.S.
S.O.S. Barbara Ann
Barbara Ann Misty Mountain Hop
Misty Mountain Hop Hey Jude
Hey Jude Loops Of Fury 2
Loops Of Fury 2 Let Forever Be
Let Forever Be Wouldn't It Be Nice
Wouldn't It Be Nice Good Vibrations
Good Vibrations California Dreamin'
California Dreamin' Menuetto KV 581
Menuetto KV 581 Polyethylene [Parts 1 & 2] (Redux)
Polyethylene [Parts 1 & 2] (Redux) Desert Island Disk
Desert Island Disk The Skye Boat Song
The Skye Boat Song Blow Away
Blow Away The Mighty Quinn
The Mighty Quinn Knives Out (Mouser Remix)
Knives Out (Mouser Remix) Every Night
Every Night Faith
Faith Ventura Highway
Ventura Highway Take A Look At Me Now
Take A Look At Me Now Licence To Kill
Licence To Kill Baby You're The Best
Baby You're The Best Tomorrow Never Dies [4K Version]
Tomorrow Never Dies [4K Version] Life Of My Own
Life Of My Own View To A Kill
View To A Kill Best Of My Love
Best Of My Love Aurora
Aurora Changing Of The Guard
Changing Of The Guard Gaza Jazz
Gaza Jazz God Is A DJ (Vox Vesperarum)
God Is A DJ (Vox Vesperarum) Day After Day
Day After Day Do Ya
Do Ya Bad Boys
Bad Boys From Russia With Love
From Russia With Love Live And Let Die (Panicked Version)
Live And Let Die (Panicked Version) Had To Cry Today
Had To Cry Today Blue Christmas
Blue Christmas Dreams
Dreams In Limbo
In Limbo Electioneering
Electioneering Sleep Together
Sleep Together House Of Cards
House Of Cards The World Is Not Enough
The World Is Not Enough Nanjing Fall
Nanjing Fall Karma Police
Karma Police I Shot The Sheriff
I Shot The Sheriff Get Up, Stand Up
Get Up, Stand Up Suspicious Minds
Suspicious Minds Good Enough
Good Enough Baby One More Time
Baby One More Time True Love
True Love Walking Back to Happiness
Walking Back to Happiness Walk Right Back
Walk Right Back Blackbird
Blackbird Shake It Off
Shake It Off Computer Love
Computer Love Clint Eastwood
Clint Eastwood I'm So Excited
I'm So Excited Needles And Pins
Needles And Pins There There (Extended Edition)
There There (Extended Edition) Handle With Care
Handle With Care Last Night
Last Night My Happiness
My Happiness Mean
Mean The Court Of The Crimson King (Redux)
The Court Of The Crimson King (Redux) Frame By Frame
Frame By Frame Shut Your Mouth
Shut Your Mouth With A Little Help From My Friends
With A Little Help From My Friends Fly Like An Eagle
Fly Like An Eagle Little By Little
Little By Little You Belong With Me
You Belong With Me Tree Fingers
Tree Fingers You've Got Another Thing Comin'
You've Got Another Thing Comin' Thunderball
Thunderball Inside My Head
Inside My Head Where Is My Mind?
Where Is My Mind? Lay Lady Lay
Lay Lady Lay The Last Train To Clarksville
The Last Train To Clarksville She's A Woman
She's A Woman Like A Rolling Stone
Like A Rolling Stone La Bamba
La Bamba HALO Theme
HALO Theme Lady Of The Dancing Water
Lady Of The Dancing Water Cirkus
Cirkus Epitaph
Epitaph Over The Rainbow
Over The Rainbow Black
Black Goldfinger
Goldfinger JAG Theme
JAG Theme Also Spracht Zarathustra
Also Spracht Zarathustra Chains
Chains Bobby Brown
Bobby Brown Out Of Time
Out Of Time White Room
White Room Rachmaninov: Prelude No. 1 in C-Sharp Minor, Op. 3 No. 2
Rachmaninov: Prelude No. 1 in C-Sharp Minor, Op. 3 No. 2 Will Of The People
Will Of The People We Are Never Ever Getting Back Together
We Are Never Ever Getting Back Together Love Is In The Air
Love Is In The Air Crossroads 1968
Crossroads 1968 Crossroads 1936
Crossroads 1936 Black
Black Auf Weidersehen
Auf Weidersehen The Imperial March
The Imperial March Red Red Wine
Red Red Wine Still Got The Blues [For You]
Still Got The Blues [For You] Born Slippy [Hurler Version]
Born Slippy [Hurler Version] Liberation
Liberation Love Story
Love Story My Country
My Country Dueling Banjos
Dueling Banjos Blue Skies
Blue Skies Nothing Else Matters
Nothing Else Matters (Been) Thinking About You
(Been) Thinking About You Waldstein (No. 2)
Waldstein (No. 2) Ain't That A Shame
Ain't That A Shame 21st Century Schizoid Man
21st Century Schizoid Man Crying Shame
Crying Shame Soul Sacrifice
Soul Sacrifice Never Goin' Back Again
Never Goin' Back Again Come On My My Kitchen
Come On My My Kitchen Boys
Boys Surrender
Surrender Empty Garden
Empty Garden Turn! Turn! Turn!
Turn! Turn! Turn! Faust Arp (Dante's Waltz Version)
Faust Arp (Dante's Waltz Version) Let Down
Let Down No Surprises
No Surprises Prove Yourself
Prove Yourself James Bond Theme
James Bond Theme Dream Police
Dream Police The Scientist
The Scientist Myxomatosis (Burning Black Hole Version)
Myxomatosis (Burning Black Hole Version) The Concerto for Two Violins in Dm, BWV 1043: 3
The Concerto for Two Violins in Dm, BWV 1043: 3 The Concerto for Two Violins in Dm, BWV 1043: 2
The Concerto for Two Violins in Dm, BWV 1043: 2 The Concerto for Two Violins in Dm, BWV 1043: 1
The Concerto for Two Violins in Dm, BWV 1043: 1 Knockin' On Heaven's Door
Knockin' On Heaven's Door Bad Moon Rising
Bad Moon Rising Viva La Vida
Viva La Vida Bodysnatchers (Pod Edition)
Bodysnatchers (Pod Edition) What Do You Want From Me
What Do You Want From Me Get It On (Bang A Gong)
Get It On (Bang A Gong) I'm Not In Love
I'm Not In Love Waldstein
Waldstein Stockholm Syndrome
Stockholm Syndrome Teenage Dirtbag
Teenage Dirtbag The Low Spark Of High-Heeled Boys
The Low Spark Of High-Heeled Boys Gimme Some Lovin'
Gimme Some Lovin' Trio No.7, Op. 97: 3 & 4
Trio No.7, Op. 97: 3 & 4 Trio No.7, Op. 97: 2
Trio No.7, Op. 97: 2 Trio No.7, Op. 97: 1
Trio No.7, Op. 97: 1 Handle With Care
Handle With Care Congratulations
Congratulations Everything In It's Right Place (Two Colour Edition)
Everything In It's Right Place (Two Colour Edition) Maquiladora
Maquiladora Where Is The Love
Where Is The Love Talk Show Host [Narrowcast Version]
Talk Show Host [Narrowcast Version] Oxygene 8
Oxygene 8 Mr. Moonlight
Mr. Moonlight Plugin Baby
Plugin Baby NeverEnding Story
NeverEnding Story Euphoria (Synsational RMX)
Euphoria (Synsational RMX) Black Night
Black Night One Love (Feel Alright RMX)
One Love (Feel Alright RMX) Summer In The City
Summer In The City Oxygene, Pt. 6
Oxygene, Pt. 6 The Model (Strange Attractor)
The Model (Strange Attractor) For Your Love
For Your Love Eye Of the Tiger
Eye Of the Tiger The King Of Denmark's Galliard
The King Of Denmark's Galliard Dollars And Cents (Plastic Edition)
Dollars And Cents (Plastic Edition) The Mother We All Share
The Mother We All Share For No One (Zed RMX)
For No One (Zed RMX) Somebody's Watching Me
Somebody's Watching Me Somebody Dance With Me
Somebody Dance With Me Electric Cafe (Burts Milk Bar RMX)
Electric Cafe (Burts Milk Bar RMX) Hold The Line
Hold The Line Killing In The Name
Killing In The Name One Love (Cold Moon Edition)
One Love (Cold Moon Edition) Waiting In Vain
Waiting In Vain Fairytale of New York
Fairytale of New York Chariots Of Fire
Chariots Of Fire All Those Years Ago
All Those Years Ago Where The Streets Have No Name
Where The Streets Have No Name The End
The End Don't Fear The Reaper (Vestibular RMX)
Don't Fear The Reaper (Vestibular RMX) Africa (Hwange RMX)
Africa (Hwange RMX) My Generation
My Generation Beat It
Beat It Prayers For Rain
Prayers For Rain Under The Sea
Under The Sea There Is A Light That Never Goes Out
There Is A Light That Never Goes Out How Soon Is Now?
How Soon Is Now? This Masquerade
This Masquerade Bangladesh
Bangladesh A Day In The Life
A Day In The Life True Love Waits (Redux)
True Love Waits (Redux) 2+2=5 (The Lukewarm)
2+2=5 (The Lukewarm) Give Me Love
Give Me Love I Will
I Will Long Tall Sally
Long Tall Sally Prelude and Fugue in Em
Prelude and Fugue in Em Imagine
Imagine Rumble (In The Jungle)
Rumble (In The Jungle) High And Dry (Beached RMX)
High And Dry (Beached RMX) Just Like Heaven (Feather Cut Version)
Just Like Heaven (Feather Cut Version) Monkberry Moon Delight
Monkberry Moon Delight Photograph
Photograph Thinking About You
Thinking About You Cars
Cars Karelia Suite, Op. 11: 1. Intermezzo (Moderato)
Karelia Suite, Op. 11: 1. Intermezzo (Moderato) Symphony No. 40 in G Minor, K. 550: I. Molto allegro
Symphony No. 40 in G Minor, K. 550: I. Molto allegro Yes I Am
Yes I Am Piano Sonata No.8, Op.13 'Pathetique'
Piano Sonata No.8, Op.13 'Pathetique' Alligators In New York Sewers
Alligators In New York Sewers Land Of Confusion
Land Of Confusion Fugue
Fugue I Might Be Wrong (Redoubled)
I Might Be Wrong (Redoubled) Connected
Connected Stop Whispering (Jack's Lament)
Stop Whispering (Jack's Lament) All Things Must Pass
All Things Must Pass Ständchen (Serenade) D957-4
Ständchen (Serenade) D957-4 Eyes Wide Open
Eyes Wide Open Larks' Tongues in Aspic (Part II)
Larks' Tongues in Aspic (Part II) Starless
Starless Break On Through (To the Other Side)
Break On Through (To the Other Side) Do-Wah-Diddy
Do-Wah-Diddy Everything In It's Right Place (Free RMX)
Everything In It's Right Place (Free RMX) Ramblin' Man
Ramblin' Man Sit Down Stand Up
Sit Down Stand Up Bullet Proof ... I Wish I Was
Bullet Proof ... I Wish I Was What Becomes Of The Brokenhearted
What Becomes Of The Brokenhearted The Tourist
The Tourist Gypsy (Deluxe RMX)
Gypsy (Deluxe RMX) Squinch
Squinch Beautiful Day
Beautiful Day Tears In Heaven
Tears In Heaven Everybody's Got To Learn Sometime
Everybody's Got To Learn Sometime Ceremony
Ceremony Something Just Like This
Something Just Like This You Only Live Twice (Redux)
You Only Live Twice (Redux) Golden Eye
Golden Eye Jump
Jump Evil Woman
Evil Woman Just Like Starting Over
Just Like Starting Over Mr. K.
Mr. K. Free Fallin'
Free Fallin' All Right Now
All Right Now Moonshadow
Moonshadow Paranoid
Paranoid Give Peace A Chance
Give Peace A Chance Children Of The Sea
Children Of The Sea 25 or 6 to 4
25 or 6 to 4 If You Leave Me Now
If You Leave Me Now Anthem For The Year 2000
Anthem For The Year 2000 Another Brick In The Wall (Part II)
Another Brick In The Wall (Part II) The Air That I Breathe
The Air That I Breathe Hard As A Rock
Hard As A Rock It's Gonna Get Better
It's Gonna Get Better I Can't Dance
I Can't Dance Locomotion
Locomotion Fade Out (Again)
Fade Out (Again) Weird Fishes/ Arpeggi
Weird Fishes/ Arpeggi Underneath The Radar
Underneath The Radar Californication
Californication Lady Jane
Lady Jane Blue Suede Shoes
Blue Suede Shoes Tonight Tonight
Tonight Tonight 4 Minute Warning (Redux)
4 Minute Warning (Redux) Bones
Bones Black Hole Sun
Black Hole Sun That's The Way (I Like It)
That's The Way (I Like It) I Want You To Want Me
I Want You To Want Me Radio-Activity
Radio-Activity Musik ohne Ende
Musik ohne Ende Where I End And You Begin [Redux]
Where I End And You Begin [Redux] Lookin' Out My Back Door
Lookin' Out My Back Door Walkin' The Dog
Walkin' The Dog Under My Thumb
Under My Thumb U Got The Look
U Got The Look Purple Rain (Appalachian Plateau Version)
Purple Rain (Appalachian Plateau Version) Raspberry Beret
Raspberry Beret 1999 (Redux)
1999 (Redux) Ode To Joy
Ode To Joy Die Zauberflöte: Die Königin der Nacht
Die Zauberflöte: Die Königin der Nacht Magical Mystery Tour
Magical Mystery Tour Magic Bus
Magic Bus Burnin' For You
Burnin' For You Domino
Domino You're My Best Friend
You're My Best Friend Heart Of Glass
Heart Of Glass I Believe In Father Christmas
I Believe In Father Christmas Maneater
Maneater Creep (Slinky RMX)
Creep (Slinky RMX) Driver's Seat
Driver's Seat Whip It
Whip It Under The Milky Way
Under The Milky Way Street Hassle (Waltzing Matilda)
Street Hassle (Waltzing Matilda) Electric Blue
Electric Blue Dead End Street
Dead End Street Barabajagal
Barabajagal Airwaves
Airwaves Heartbreaker
Heartbreaker Climbing Up The Walls
Climbing Up The Walls When I Paint My Masterpiece
When I Paint My Masterpiece Shout
Shout Macarena
Macarena I'm Only Sleeping
I'm Only Sleeping Tomorrow Belongs To Me
Tomorrow Belongs To Me Airbag (Crash-Test Version)
Airbag (Crash-Test Version) My Guitar Gently Weeps
My Guitar Gently Weeps Freight Train
Freight Train 777-9311
777-9311 Nothing Compares 2 U
Nothing Compares 2 U Magic
Magic Sail To The Moon
Sail To The Moon Sweet Child O' Mine
Sweet Child O' Mine Two Strong Hearts
Two Strong Hearts All Right Now
All Right Now Country Roads
Country Roads Do Me, Baby
Do Me, Baby Rabbit (In Your Headlights)
Rabbit (In Your Headlights) No Time To Die
No Time To Die Ripcord (Redux)
Ripcord (Redux) Part-Time Lover
Part-Time Lover A Horse With No Name
A Horse With No Name When Will I Be Loved
When Will I Be Loved True Love Waits
True Love Waits Force Majeure
Force Majeure When Will I See You Again
When Will I See You Again Venus And Mars
Venus And Mars Third Stone From The Sun
Third Stone From The Sun Lady Blue
Lady Blue Only The Lonely
Only The Lonely Still... You Turn Me On
Still... You Turn Me On One Of These Days
One Of These Days Venus
Venus Teddy Boy
Teddy Boy Do You Want To Know A Secret
Do You Want To Know A Secret Rocket Man (Glastonbury Version)
Rocket Man (Glastonbury Version) Oh My Love
Oh My Love Junk
Junk Let Me Roll It
Let Me Roll It Be True To Your School
Be True To Your School Purple Rain [Madcat Edition]
Purple Rain [Madcat Edition] Philby
Philby School
School Big Love (360º Version)
Big Love (360º Version) Lurgee
Lurgee The Court Of the Crimson King
The Court Of the Crimson King Violin Concerto No. 2 in E Major, BWV 1042: 1. Allegro
Violin Concerto No. 2 in E Major, BWV 1042: 1. Allegro More Than A Feeling
More Than A Feeling Child In Time
Child In Time Rudy
Rudy Gypsy
Gypsy Moby Dick (Queequeg's Lament)
Moby Dick (Queequeg's Lament) Call Of Ktulu
Call Of Ktulu How Do You?
How Do You? Tales Of Brave Ulysses (Sirens Chorus)
Tales Of Brave Ulysses (Sirens Chorus) Outside Woman Blues
Outside Woman Blues True
True Golden Brown
Golden Brown Highway Star
Highway Star Sister Moonshine
Sister Moonshine Chicago
Chicago Gold
Gold Dirty Work
Dirty Work Ordinary World
Ordinary World Hold Me
Hold Me Just (Conflict Resolution Version)
Just (Conflict Resolution Version) Machine Gun
Machine Gun American Pie
American Pie Little Red Corvette
Little Red Corvette Meeting In The Aisle
Meeting In The Aisle Mystery To Me
Mystery To Me Autobahn (EV Version)
Autobahn (EV Version) The Model (The DIVA's Return)
The Model (The DIVA's Return) A Saucerful Of Secrets
A Saucerful Of Secrets Round And Around
Round And Around Comfortably Numb (Methos RMX)
Comfortably Numb (Methos RMX) Highway To Hell
Highway To Hell Hypnotized
Hypnotized Oh Well
Oh Well You
You A Place In The Sun
A Place In The Sun Myxomatosis
Myxomatosis One Love
One Love Robotronik
Robotronik Paperback Writer
Paperback Writer I've Seen All Good People
I've Seen All Good People Pocket Calculator (NOVA Version)
Pocket Calculator (NOVA Version) Neon Lights (PTEq-X Version)
Neon Lights (PTEq-X Version) Pictures Of You (CODE RED Version)
Pictures Of You (CODE RED Version) Neon Lights
Neon Lights Wild Horses
Wild Horses Pictures Of You
Pictures Of You Pocket Calculator
Pocket Calculator Franz Schubert
Franz Schubert Tarkus (Trinity RMX)
Tarkus (Trinity RMX) Videotape (Rewound)
Videotape (Rewound) Radioactivity
Radioactivity From The Beginning
From The Beginning Tour de France
Tour de France Vegetable
Vegetable Benny
Benny The Robots
The Robots Hoedown
Hoedown Man-Machine
Man-Machine Interstellar Overdrive (Mess-Hall RMX)
Interstellar Overdrive (Mess-Hall RMX) Run Like Hell (IPCC Version)
Run Like Hell (IPCC Version) Uptown Girl
Uptown Girl Interstellar OD
Interstellar OD Oxygene, Pt. 4
Oxygene, Pt. 4 Oxygene, Pt. 6
Oxygene, Pt. 6 Prove Yourself
Prove Yourself Hungry Like The Wolf
Hungry Like The Wolf I Can't
I Can't London Calling
London Calling Graceland
Graceland West End Girls
West End Girls Us And Them
Us And Them Enola Gay
Enola Gay ChatGPT: Gilmour Riff
ChatGPT: Gilmour Riff Computerwelt
Computerwelt Electric Cafe
Electric Cafe Nothing As It Seems (Redux)
Nothing As It Seems (Redux) Beds Are Burning
Beds Are Burning Africa Unite
Africa Unite It's Raining Again
It's Raining Again Sunshine Day (Redux)
Sunshine Day (Redux) Castles Made Of Sand
Castles Made Of Sand Special
Special We Suck Young Blood
We Suck Young Blood Private Eyes
Private Eyes Caribbean Queen
Caribbean Queen Epic
Epic Beautiful Child
Beautiful Child Exodus
Exodus Tomorrow
Tomorrow If I Needed Someone
If I Needed Someone Bring It On Home To Me
Bring It On Home To Me Steal My Kisses
Steal My Kisses God Only Knows (Multi-Part RMX)
God Only Knows (Multi-Part RMX) White Flag
White Flag Never Let Me Down Again
Never Let Me Down Again Pretzel Logic
Pretzel Logic Listen To The Music
Listen To The Music Knives Out
Knives Out Man! I Feel Like A Woman!
Man! I Feel Like A Woman! Bell Bottom Blues
Bell Bottom Blues Go Slowly
Go Slowly Blow Out
Blow Out Take The Power Back
Take The Power Back Bullet In The Head
Bullet In The Head Live And Let Die
Live And Let Die Licence To Kill
Licence To Kill Banana Co
Banana Co Smoke On the Water
Smoke On the Water The Unforgiven (Supplication RMX)
The Unforgiven (Supplication RMX) Are You Lonesome Tonight?
Are You Lonesome Tonight? War Pigs
War Pigs Marrakesh Express
Marrakesh Express Brown Sugar
Brown Sugar Nowhere Man
Nowhere Man Teach Your Children
Teach Your Children Gimme Shelter (Bushmaster RMX)
Gimme Shelter (Bushmaster RMX) Violin Concerto in D Major, Op. 61: 1
Violin Concerto in D Major, Op. 61: 1 Wait Until Tomorrow (Uneasy RMX)
Wait Until Tomorrow (Uneasy RMX) Do It Again
Do It Again Our House
Our House Suite: Judy Blue Eyes (Extended Mix)
Suite: Judy Blue Eyes (Extended Mix) Lozenge Of Love
Lozenge Of Love Southern Cross
Southern Cross Speed Of Sound
Speed Of Sound Bodhisattva (Extended Mix)
Bodhisattva (Extended Mix) Paradise
Paradise Heart Of Stone
Heart Of Stone Ceremony
Ceremony Separator
Separator Mr Tambourine Man
Mr Tambourine Man Sonata 13, in BbM, KV 333
Sonata 13, in BbM, KV 333 Do Wah Diddy Diddy
Do Wah Diddy Diddy Whip It!
Whip It! Eye Of The Tiger
Eye Of The Tiger The King of Denmark's Galliard
The King of Denmark's Galliard I've Just Seen A Face
I've Just Seen A Face Blue Monday (Joyful RMX)
Blue Monday (Joyful RMX) Blue Monday (Emu RMX)
Blue Monday (Emu RMX) If We Ever Meet Again
If We Ever Meet Again Blue Monday
Blue Monday Greensleeves (Jeff Beck Version)
Greensleeves (Jeff Beck Version) Regret
Regret The Rockets Red Glare
The Rockets Red Glare Evil Ways
Evil Ways Moonlight Sonata, Op. 27, No. 2 (First Movement)
Moonlight Sonata, Op. 27, No. 2 (First Movement) Jesu Joy Of Man's Desiring (Guitar + Kalimba)
Jesu Joy Of Man's Desiring (Guitar + Kalimba) The Last Time (Kalimba Synth)
The Last Time (Kalimba Synth) The Last Time
The Last Time Glass Onion
Glass Onion Big Ideas
Big Ideas Dream Weaver
Dream Weaver It's All Over Now
It's All Over Now The Present Tense (Past Participle)
The Present Tense (Past Participle) (You Gotta) Fight For Your Right (To Party!)
(You Gotta) Fight For Your Right (To Party!) Rip This Joint (Tally-Ho RMX)
Rip This Joint (Tally-Ho RMX) The Chain
The Chain Your Cheatin' Heart
Your Cheatin' Heart Dancing With The Moonlit Knight
Dancing With The Moonlit Knight Pictures At An Exhibition
Pictures At An Exhibition God Is A DJ (Bliss RMX)
God Is A DJ (Bliss RMX) The Hippy Hippy Shake
The Hippy Hippy Shake The Trickster
The Trickster Thunderstruck (Santus Remisceo)
Thunderstruck (Santus Remisceo) Drive
Drive Knockin' On Heaven's Door (Weeping Angel Version)
Knockin' On Heaven's Door (Weeping Angel Version) Only The Lonely (Sirens RMX)
Only The Lonely (Sirens RMX) Sweet Virginia
Sweet Virginia Hey Jude
Hey Jude Black Magic Woman
Black Magic Woman I'm So Lonesome I Could Cry
I'm So Lonesome I Could Cry Rubber Duckie
Rubber Duckie Telstar
Telstar Don't Stop
Don't Stop How To Disappear Completely (Tired RMX)
How To Disappear Completely (Tired RMX) Die Mensch-Machine
Die Mensch-Machine Dreams
Dreams Mind Games
Mind Games You Make Loving Fun
You Make Loving Fun Jesu Joy Of Man's Desiring
Jesu Joy Of Man's Desiring Rhiannon
Rhiannon Xmas Bells (Ukraine)
Xmas Bells (Ukraine) Little Lies
Little Lies Songbird (Extended RMX)
Songbird (Extended RMX) Say You Love Me (Wendy RMX)
Say You Love Me (Wendy RMX) Go Your Own Way
Go Your Own Way Worried Man
Worried Man The Bends
The Bends Flash
Flash Salve Radix [The Rose Canon]
Salve Radix [The Rose Canon] Stop Whispering
Stop Whispering Seven Zero
Seven Zero White Shadows
White Shadows Cruel Summer
Cruel Summer All I Need
All I Need Kailash
Kailash Besame Mucho
Besame Mucho Codex
Codex Lachrimae
Lachrimae Fantaisie-Impromptu
Fantaisie-Impromptu Tumbling Dice
Tumbling Dice Stormy Monday
Stormy Monday Go To Sleep
Go To Sleep Sadeness
Sadeness Brazil
Brazil How I Made My Millions
How I Made My Millions Baby Blue
Baby Blue Die Another Day (Profane RMX)
Die Another Day (Profane RMX) Catch The Wind
Catch The Wind Star Trek
Star Trek November Rain
November Rain Stardust
Stardust Steam
Steam The World Is Not Enough (Redux)
The World Is Not Enough (Redux) They Call Me The Breeze
They Call Me The Breeze And You And I
And You And I Africa
Africa Clocks
Clocks Crazy Little Thing Called Love
Crazy Little Thing Called Love Pick Up The Pieces
Pick Up The Pieces She Blinded Me With Science
She Blinded Me With Science Pop Is Dead
Pop Is Dead Hot Stuff
Hot Stuff Jerusalem
Jerusalem Boombastic
Boombastic Govindam
Govindam Mission Impossible (Durga Temple RMX)
Mission Impossible (Durga Temple RMX) Just (Stinky Version)
Just (Stinky Version) Tales Of Brave Ulysses
Tales Of Brave Ulysses Her Majesty
Her Majesty Here Comes The Sun
Here Comes The Sun Skyfall
Skyfall Lovesong
Lovesong Paperback Writer
Paperback Writer Got To Get You Into My Life
Got To Get You Into My Life I'm Only Sleeping
I'm Only Sleeping Goodbye Yellow Brick Road
Goodbye Yellow Brick Road Whole Lotta Shakin' Goin' On
Whole Lotta Shakin' Goin' On Bangers And Mash
Bangers And Mash Yellow
Yellow Something So Strong
Something So Strong Watching The Wheels Go By
Watching The Wheels Go By Fake Plastic Trees (ISS Version)
Fake Plastic Trees (ISS Version) No Woman No Cry
No Woman No Cry Around The World
Around The World You Only Live Twice
You Only Live Twice Bodysnatchers
Bodysnatchers Bulletproof
Bulletproof Sulk
Sulk I Might Be Wrong [Voice Box Version]
I Might Be Wrong [Voice Box Version] High & Dry [Voice Box Version]
High & Dry [Voice Box Version] Let Down [Voice Box Version]
Let Down [Voice Box Version] The Ipcress File
The Ipcress File Deserted Cities Of The Heart
Deserted Cities Of The Heart She Came In Through The Bathroom Window
She Came In Through The Bathroom Window Sunshine Of Your Love
Sunshine Of Your Love Where I End And You Begin
Where I End And You Begin Moon River
Moon River Ripcord
Ripcord Du Hast
Du Hast Trans-Europe Express
Trans-Europe Express The Ragpicker's Dream
The Ragpicker's Dream Sultans Of Swing
Sultans Of Swing Up On The Roof
Up On The Roof Cry Baby Cry
Cry Baby Cry Spectral Mornings
Spectral Mornings I Feel Love
I Feel Love Endless Love
Endless Love Radar Love
Radar Love Big-time Sensuality
Big-time Sensuality Honky Tonk Women
Honky Tonk Women Born Under A Bad Sign (T-Bone Version)
Born Under A Bad Sign (T-Bone Version) All You Need Is Love
All You Need Is Love New Born
New Born Morning Bell (Bellicose Version)
Morning Bell (Bellicose Version) (Nice Dream)
(Nice Dream) Key To The Highway
Key To The Highway I Want You (She's So Heavy) [XTD Version]
I Want You (She's So Heavy) [XTD Version] I Want You (She's So Heavy)
I Want You (She's So Heavy) Rain
Rain Blue Sky Mine
Blue Sky Mine Can't Find My Way Home
Can't Find My Way Home The Middle
The Middle Nivram
Nivram Unchained Melody
Unchained Melody Kontiki
Kontiki The Savage
The Savage Building The Church
Building The Church Botany Bay
Botany Bay Deutschlandlied
Deutschlandlied My Happiness
My Happiness What You Need
What You Need The Song Of Australia
The Song Of Australia A Pub With No Beer
A Pub With No Beer Apache (Redux)
Apache (Redux) Choir Girl
Choir Girl God Save The King
God Save The King On Her Majesty's Secret Service
On Her Majesty's Secret Service Fall Dog Bombs The Moon
Fall Dog Bombs The Moon Elephant (Redux)
Elephant (Redux) Requiem in D Minor, K 626: 7. Agnes Dei, 8. Communio
Requiem in D Minor, K 626: 7. Agnes Dei, 8. Communio Requiem in D Minor, K 626: 1. Introitus
Requiem in D Minor, K 626: 1. Introitus The Wild Colonial Boy
The Wild Colonial Boy If Not For You
If Not For You Into The Mystic
Into The Mystic Rawhide
Rawhide The Lone Ranger (Redux)
The Lone Ranger (Redux) William Tell (Overture)
William Tell (Overture) Perry Mason
Perry Mason Australia
Australia Motorcycle Emptiness
Motorcycle Emptiness Ghost Riders In The Sky
Ghost Riders In The Sky Atlantis
Atlantis I Want None Of This
I Want None Of This Goldfinger
Goldfinger Drive My Car
Drive My Car I Can See For Miles
I Can See For Miles Take The Long Way Home
Take The Long Way Home Peace
Peace Blow The Man Down
Blow The Man Down Nobody Does It Better
Nobody Does It Better Beds Are Burning
Beds Are Burning The Unforgiven
The Unforgiven BWV 1043 Concerto For Two Violins, Andante
BWV 1043 Concerto For Two Violins, Andante Verstohlen geht der Mond auf
Verstohlen geht der Mond auf The Voice
The Voice The Less I Know The Better
The Less I Know The Better I Will Sing My Maker's Praises
I Will Sing My Maker's Praises The Black Forest
The Black Forest Oberek
Oberek The Colony
The Colony The Three Ravens
The Three Ravens Flowers Of The Forest
Flowers Of The Forest The Ocean
The Ocean Becalmed
Becalmed The Lancers Set
The Lancers Set Die Mazurka des Skjold
Die Mazurka des Skjold Bound For South Australia
Bound For South Australia Hamburg
Hamburg Berlin
Berlin The Barges
The Barges Lamentation
Lamentation Fleeing Oppression
Fleeing Oppression Hedwig's Peal
Hedwig's Peal Wender
Wender Trilogy
Trilogy Electric Ladyland
Electric Ladyland Neutron Dance
Neutron Dance Run Through The Jungle
Run Through The Jungle You've Got To Hide Your Love Away
You've Got To Hide Your Love Away 1999
1999 This Is Not America
This Is Not America You and Who's Army?
You and Who's Army? 1979
1979 DUNE
DUNE All The Small Things
All The Small Things Closer
Closer Head Like A Hole
Head Like A Hole The Perfect Drug
The Perfect Drug Enter Sandman
Enter Sandman A Forest
A Forest Fascination Street
Fascination Street World In My Eyes
World In My Eyes Despacito
Despacito Just Like Heaven
Just Like Heaven Man Of War
Man Of War Big Boots (Man Of War)
Big Boots (Man Of War) Westworld
Westworld Freedom
Freedom Take A Pebble
Take A Pebble Talk Show Host
Talk Show Host Aeroplane
Aeroplane (I've seen) All Good People
(I've seen) All Good People I Go To Rio
I Go To Rio Street Spirit
Street Spirit Dear Prudence
Dear Prudence The National Anthem
The National Anthem Blade Runner
Blade Runner Present Tense
Present Tense Sail To The Moon
Sail To The Moon Good Lovin'
Good Lovin' Idioteque
Idioteque Rikki Don't Lose That Number
Rikki Don't Lose That Number Let Down
Let Down Pyramid Song
Pyramid Song Black
Black Inception
Inception Popcorn
Popcorn Little Wing (Reduxed)
Little Wing (Reduxed) I Will
I Will The Rise and Fall of Flingel Bunt
The Rise and Fall of Flingel Bunt Jeepster
Jeepster Sirtaki
Sirtaki Heroes
Heroes Jin-Go
Jin-Go Bold As Love
Bold As Love Good Vibrations
Good Vibrations Kokomo
Kokomo Black Star (Resilient RMX)
Black Star (Resilient RMX) Nantucket Sleighride
Nantucket Sleighride Sofa No. 3
Sofa No. 3 Souvenir de Chine
Souvenir de Chine Optimistic (Jurassic RMX)
Optimistic (Jurassic RMX) Scatterbrain
Scatterbrain Life In A Glass House #2
Life In A Glass House #2 Diva Dance
Diva Dance The Fifth Element Theme
The Fifth Element Theme Because The Night
Because The Night We Belong
We Belong Shadows Of The Night
Shadows Of The Night She's A Rainbow
She's A Rainbow A Man Without Love
A Man Without Love Fremdling
Fremdling Fremdling (Part 1)
Fremdling (Part 1) Fremdling (Part 2)
Fremdling (Part 2) Under The Boardwalk [Redux]
Under The Boardwalk [Redux] When The Levee Breaks
When The Levee Breaks The Numbers
The Numbers Nude
Nude Sommernachtstraum und Begleitmusik (Part 2)
Sommernachtstraum und Begleitmusik (Part 2) Bad Boy
Bad Boy Sommernachtstraum und Begleitmusik [Part 1]
Sommernachtstraum und Begleitmusik [Part 1] California Dreaming
California Dreaming Concerto in A minor for Four Harpsichords, BWV 1065
Concerto in A minor for Four Harpsichords, BWV 1065 China Girl
China Girl Orchestral Suite No. 3 in D Major, BWV 1068 [2nd Movement]
Orchestral Suite No. 3 in D Major, BWV 1068 [2nd Movement] I Am The Walrus (Xpert RMX)
I Am The Walrus (Xpert RMX) Roll Over Beethoven
Roll Over Beethoven Clarinet Concerto in A Major, K. 622
Clarinet Concerto in A Major, K. 622 Symphony No. 5 [1st Movement: Allegro con brio]
Symphony No. 5 [1st Movement: Allegro con brio] I Might Be Wrong (For Lviv)
I Might Be Wrong (For Lviv) Cosmic Love
Cosmic Love (Just Like) Spinning Plates
(Just Like) Spinning Plates Sail Away
Sail Away Sailing
Sailing Bohemian Rhapsody
Bohemian Rhapsody My Iron Lung
My Iron Lung Hurts So Good
Hurts So Good Kashmir
Kashmir Let My Love Open The Door
Let My Love Open The Door Dust In The Wind
Dust In The Wind The Reflex
The Reflex Living Sin
Living Sin Zebra
Zebra You Never Wash Up After Yourself
You Never Wash Up After Yourself All The Things You Are
All The Things You Are Ukranian National Anthem (Grey Wolf RMX)
Ukranian National Anthem (Grey Wolf RMX) La Vie En Rose
La Vie En Rose Personal Jesus (Pantocrator RMX)
Personal Jesus (Pantocrator RMX) Peggy Sue
Peggy Sue Polyethylene [Parts 1 & 2]
Polyethylene [Parts 1 & 2] I Am The Walrus
I Am The Walrus Die Another Day
Die Another Day The Young Ones
The Young Ones Surf Rider
Surf Rider Ride Like The Wind
Ride Like The Wind Fanfare For The Common Man
Fanfare For The Common Man What You Need
What You Need Mission: Impossible Theme
Mission: Impossible Theme Ukraine: National Anthem
Ukraine: National Anthem Exit Music (For A Film)
Exit Music (For A Film) Karma Police
Karma Police A Whiter Shade Of Pale (Synesthesia RMX)
A Whiter Shade Of Pale (Synesthesia RMX) A Whiter Shade Of Pale (Resurrection RMX)
A Whiter Shade Of Pale (Resurrection RMX) A Whiter Shade Of Pale
A Whiter Shade Of Pale Jigsaw Falling Into Place
Jigsaw Falling Into Place A Night Like This
A Night Like This Lotus Flower
Lotus Flower Tarkus (Part 2)
Tarkus (Part 2) Tarkus (Part 1)
Tarkus (Part 1) Rock 'n' Roll High School
Rock 'n' Roll High School Mazurka in GM, [Opus 50, No. 1]
Mazurka in GM, [Opus 50, No. 1] Neon Lights
Neon Lights Paranoid Android
Paranoid Android Awake Sweet Love [thou art returned]
Awake Sweet Love [thou art returned] Item de Virginibus (Redux)
Item de Virginibus (Redux) Optimistic
Optimistic Fugue in CM [Hess 236, No. 9]
Fugue in CM [Hess 236, No. 9] Touch And Go
Touch And Go Autobahn (Roadtrain RMX)
Autobahn (Roadtrain RMX) Wolf At The Door
Wolf At The Door Handle With Care
Handle With Care Fly Me To The Moon [In Other Words]
Fly Me To The Moon [In Other Words] Runaway
Runaway Fake Plastic Trees
Fake Plastic Trees Born Slippy [NUXX]
Born Slippy [NUXX] God Only Knows (Resilient RMX)
God Only Knows (Resilient RMX) Please Don't Go
Please Don't Go Time (Omicron RMX)
Time (Omicron RMX) Boom, Boom, Boom, Boom
Boom, Boom, Boom, Boom If Not For You
If Not For You Mystify
Mystify High And Dry
High And Dry Birthday
Birthday Oh Yoko!
Oh Yoko! Gimme Shelter
Gimme Shelter Inception
Inception 4 Minute Warning
4 Minute Warning Highland Fairy Lullaby
Highland Fairy Lullaby Instant Karma (Redux)
Instant Karma (Redux) The Land Down Under
The Land Down Under Wipeout
Wipeout Starship Trooper
Starship Trooper Midnight Rambler (Kitchen Door RMX)
Midnight Rambler (Kitchen Door RMX) Time Is On My Side
Time Is On My Side Reckoner (Ready RMX)
Reckoner (Ready RMX) Lucky (Plan 9 Western RMX)
Lucky (Plan 9 Western RMX) Walking The Dog
Walking The Dog Close To The Edge
Close To The Edge C.C. Rider
C.C. Rider Reelin' In The Years
Reelin' In The Years From Russia With Love
From Russia With Love Das wohltemperierte Klavier II, BWV 870
Das wohltemperierte Klavier II, BWV 870 Videotape
Videotape Blow Out
Blow Out Killing Me Softly
Killing Me Softly Peter and The Wolf
Peter and The Wolf Peter and The Wolf (Part 2)
Peter and The Wolf (Part 2) Peter and The Wolf (Part 1)
Peter and The Wolf (Part 1) Nothing Else Matters
Nothing Else Matters Misirlou
Misirlou Rumble
Rumble Motion Picture Soundtrack
Motion Picture Soundtrack The Expanse 2
The Expanse 2 Must Be Santa
Must Be Santa In The End
In The End Witchy Woman
Witchy Woman Lucky Man
Lucky Man The Bends
The Bends Peaceful Easy Feeling
Peaceful Easy Feeling Don't Fear The Reaper (Redux)
Don't Fear The Reaper (Redux) Take It Easy (Borg RMX)
Take It Easy (Borg RMX) Every Little Thing
Every Little Thing Bodysnatchers
Bodysnatchers Ain't She Sweet
Ain't She Sweet A Groovy Kind Of Love
A Groovy Kind Of Love Surf Rider
Surf Rider How Bizarre
How Bizarre Chor Credo In Unum Deum
Chor Credo In Unum Deum A Question Of Lust
A Question Of Lust Year Of The Cat
Year Of The Cat Sitting On Top Of The World (Bolton RMX)
Sitting On Top Of The World (Bolton RMX) Sitting On Top Of The World (Redux)
Sitting On Top Of The World (Redux) Black Is The Colour Of My True Love's Hair
Black Is The Colour Of My True Love's Hair Street Spirit
Street Spirit Only The Lonely
Only The Lonely White Rabbit
White Rabbit (Like) Spinning Plates
(Like) Spinning Plates Big Love
Big Love End Of The Line
End Of The Line Psalm 69
Psalm 69 Wishing Well
Wishing Well Let There Be Drums '21 (Delta RMX)
Let There Be Drums '21 (Delta RMX) No Time To Die (Redux)
No Time To Die (Redux) Heart-Shaped Box
Heart-Shaped Box Say You Love Me
Say You Love Me New Born
New Born Interstellar (Redux)
Interstellar (Redux) Supermassive Black Hole
Supermassive Black Hole Doctor Who (Redux)
Doctor Who (Redux) Welcome To The Machine
Welcome To The Machine True Faith
True Faith Sweet Jane
Sweet Jane So-me-thing
So-me-thing Wonderful Life
Wonderful Life This Is The One [Welcome Home RMX]
This Is The One [Welcome Home RMX] (Song For My) Sugar Spun Sister
(Song For My) Sugar Spun Sister I'm On Fire
I'm On Fire The Mighty Quinn (Quinn the Eskimo)
The Mighty Quinn (Quinn the Eskimo) Here Comes Your Man
Here Comes Your Man Can You [Point Your Fingers and Do The Twist]
Can You [Point Your Fingers and Do The Twist] Too Many People
Too Many People Can't Find My Way Home
Can't Find My Way Home Walking In My Shoes (Delta RMX)
Walking In My Shoes (Delta RMX) Hideaway
Hideaway Subterranean Homesick Alien
Subterranean Homesick Alien In The End
In The End The Norefjell Theme
The Norefjell Theme Reckoner
Reckoner Exit Music [For A Film]
Exit Music [For A Film] In My Life (Transfixed RMX)
In My Life (Transfixed RMX) Nothing As It Seems
Nothing As It Seems Guns Of Brixton
Guns Of Brixton Mission Impossible Theme
Mission Impossible Theme Wayfaring Stranger
Wayfaring Stranger Echoes
Echoes The Power Of Love
The Power Of Love Venus
Venus Wrong Number
Wrong Number There There
There There Punch Up At A Wedding (Broken RMX)
Punch Up At A Wedding (Broken RMX) Loops Of Fury
Loops Of Fury I Run Away
I Run Away Fantasy
Fantasy This Strange Effect
This Strange Effect Sour Times
Sour Times Dancing Days (How The West Was Won)
Dancing Days (How The West Was Won) Badge
Badge How Beautiful You Are (Inspiration4 RMX)
How Beautiful You Are (Inspiration4 RMX) Silent Lucidity (Delta RMX)
Silent Lucidity (Delta RMX) The Windjammer
The Windjammer The World Is Not Enough
The World Is Not Enough Brown Sugar
Brown Sugar Everything In It's Right Place (Delta RMX)
Everything In It's Right Place (Delta RMX) Torn
Torn Down Is The New Up
Down Is The New Up Born Under A Bad Sign (Delta RMX)
Born Under A Bad Sign (Delta RMX) Got To Get Better In A Little While
Got To Get Better In A Little While Cherry Bomb
Cherry Bomb I Think I'm Paranoid (Delta RMX)
I Think I'm Paranoid (Delta RMX) Goin' Up The Country (Redux)
Goin' Up The Country (Redux) Black Star (Delta RMX)
Black Star (Delta RMX) Under Pressure (Delta RMX)
Under Pressure (Delta RMX) Watermelon In Easter Hay (Delta RMX)
Watermelon In Easter Hay (Delta RMX) White Room
White Room Planet Telex
Planet Telex Redemption Song
Redemption Song Shout To The Top!
Shout To The Top! Tell Me
Tell Me Life In A Glass House
Life In A Glass House Cocaine
Cocaine Moby Dick
Moby Dick Born Slippy .NUXX (Delta RMX)
Born Slippy .NUXX (Delta RMX) Going To California (Delta RMX)
Going To California (Delta RMX) I Might Be Wrong (Delta RMX)
I Might Be Wrong (Delta RMX) Cold Cold Heart
Cold Cold Heart Get It On
Get It On Take On Me
Take On Me Astral Traveller
Astral Traveller Little Martha
Little Martha Statesboro Blues (Delta RMX)
Statesboro Blues (Delta RMX) Melissa
Melissa For No One
For No One One Of These Days
One Of These Days Elephant
Elephant Foolin'
Foolin' Round And Around (Delta RMX)
Round And Around (Delta RMX) Photograph
Photograph Riders On The Storm
Riders On The Storm Billy's Got A Gun
Billy's Got A Gun Climbing Up The Walls (Delta RMX)
Climbing Up The Walls (Delta RMX) Never Tear Us Apart
Never Tear Us Apart I Saved The World Today
I Saved The World Today No More I Love You's
No More I Love You's This Is The One (Delta RMX)
This Is The One (Delta RMX) Everlong
Everlong I Wanna Be Adored (Delta RMX)
I Wanna Be Adored (Delta RMX) Made Of Stone
Made Of Stone It's All Over Now
It's All Over Now 19th Nervous Breakdown
19th Nervous Breakdown You Can't Always Get What You Want
You Can't Always Get What You Want Mothers Little Helper
Mothers Little Helper Get Off My Cloud
Get Off My Cloud Midnight Rambler
Midnight Rambler Stitch
Stitch